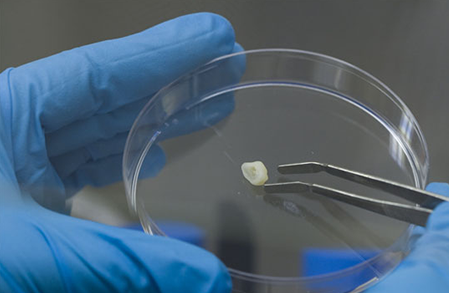

“昨日一去不復(fù)回”今天的你已經(jīng)不是昨天的你,因為我們身體中每天都會有新的細胞代替凋亡的細胞。我們身體內(nèi)的干細胞會隨著年齡的增長而惡化,而這種干細胞的衰退會導致我們身體某些功能的喪失以及疾病的發(fā)生。
干細胞是就好像是身體的“修理工”,但是會因為年齡的增長而變得疲倦與懶惰,所以就會導致疾病的發(fā)生與衰老。研究人員推測,或許有一天可以逆轉(zhuǎn)干細胞衰退,讓身體恢復(fù)活力。
干細胞衰退導致功能障礙和衰老

干細胞衰退的結(jié)果就是器官壽命有限。事實上,衰老的一個主要標志是身體內(nèi)老化的組織無法得到替代,這主要是因為干細胞的衰退導致的。
然而,研究人員推測,他們可以操縱成體干細胞,使其恢復(fù)到更年輕的狀態(tài),從而對抗干細胞的衰退。如果實現(xiàn)這個推測,那么體內(nèi)的組織和器官將會恢復(fù)活力,增加生活中健康的歲月。
再生醫(yī)學逆轉(zhuǎn)干細胞衰退

科學家們相信,在不久的將來,干細胞可以被用于再生醫(yī)學的應(yīng)用。隨著干細胞的正確使用,它們可以再生大部分器官,并使免疫系統(tǒng)恢復(fù)活力。
如果沒有干細胞的衰退,當我們失去了器官或四肢時,就可以像蜥蜴一樣再生新的。在干細胞治療中,醫(yī)生通過用新鮮的干細胞來替代受損或死亡的組織來治療疾病。
研究人員推測,干細胞療法可以治療多種疾病,包括帕金森病、阿爾茨海默病、中風、脊髓損傷、心臟病、糖尿病、類風濕性關(guān)節(jié)炎和骨關(guān)節(jié)炎。
干細胞療法已經(jīng)在使用
醫(yī)生們已經(jīng)在實踐干細胞療法來恢復(fù)受損的骨髓。在某些癌癥的治療中,化療會破壞骨髓中的所有細胞,包括其中的干細胞。
在癌癥治療后,醫(yī)生將提取的新鮮干細胞移植到癌癥治療中。為了恢復(fù)骨髓和干細胞,醫(yī)生們從健康的捐贈者身上移植少量骨髓,最終產(chǎn)生足夠的干細胞。
新生干細胞的發(fā)現(xiàn)
來源于牙齒的口腔干細胞是干細胞界的新星,來源活性更強,細胞的增殖、分化及免疫調(diào)節(jié)能力也更強。從牙髓分離出的間充質(zhì)干細胞,對于中風、神經(jīng)系統(tǒng)疾病、軟硬組織損傷有著極大的優(yōu)勢。
干細胞與再生醫(yī)學

傳言干細胞是治療所有與年齡有關(guān)的疾病的“靈丹妙藥”,其實主要也是因為它的再生機制,能夠打破常規(guī)的治療方法,開啟一個新的醫(yī)學時代。
再生醫(yī)學是一個迅速發(fā)展的研究領(lǐng)域,干細胞與再生醫(yī)學具有重大的臨床應(yīng)用價值,對疾病的機理研究和臨床運用將帶來革命性化。
| 乖乖女从小被C到大H补课1视频| 51精产国品一二三产区区别| 99久久精品费精品国产| 伊人婷婷涩六月丁香七月| 久久久久久久久久久96av| 极品人妻VIDEOSSS人妻| 髙清国产性猛交XXXAND| 牲高潮99爽久久久久777| 免费播放一区二区三区| 影音先锋av资源看波波| 狠狠CAO日日穞夜夜穞AV| 最爽最刺激18禁视频| 久久九九日本韩国精品| 黑人狂躁日本妞无码A片| 久久er热这里只有精品23| 秋霞无码AV久久久精品| 宅男午夜大片又黄又爽大片| 成年美女黄网站色大免费全看 | 亚洲精品久久国产高清小说| 国产亚洲精品久久精品录音| 国产丰满老熟妇乱XXX| 白洁被C到高潮疯狂喷水在线观看 色欲av亚洲情无码av蜜桃 | 日本精品无码一区二区三区久久久 | 99久久亚洲精品日本无码| 五月色婷婷丁香无码三级| 精品日韩卡1二2卡3卡4卡乱码 | 97SE亚洲国产综合自在线不卡| 阿v天堂2018在无码免费| 老女人与小伙子露脸对白| 国产亚洲精品久久久999苍井空| 亚洲精品久久久久久中文| 免费精品国产自产拍在线观看图片| 精品国产乱码久久久久久夜深人妻 | 人妻免费久久久久久久了| 亚洲国产日韩欧美高清片a| 国产成人无码精品久久久影院| 最近2018中文字幕视频免费看| 在线视频久久只有精品| 亚洲成人视频在线观看| 黑人亚洲精品A片久久99| 高清无码午夜福利在线观看| 亚洲国产无线乱码在线观看| 曰本一道本久久88不卡| 无码高潮又爽又黄A片软件| 亚洲精品久久久久一区二区三| 五月婷婷综合缴猜| 久久精品出轨人妻国产| 欧美顶级A片狂欢| 色情按摩XXXX视频| 在线观看日韩一区| 国产精品呻吟AV久久高潮| 国产亚洲精品久久AV| 久久国产Av无码一区二区老太| 午夜成人性爽爽免费视频| 国内熟女精品熟女A片小说| va天堂va亚洲va影视中文字幕| 香蕉人妻AV久久久久天天| 西西4444www无码大胆| 撕开奶罩揉吮奶头A片久久小说| 国产精品A久久久久久久久| 欧美A级肉欲大片XXX| 夜夜躁天天躁很躁MBA| 欧美成a人片免费看久久| yy6080午夜色情理伦片在线| 国产揉捏爆乳巨胸挤奶视频| 精品国产高清毛片A片看| 51精产国品一二三产区区别| 欧美精品A片XXX| 无码精品人妻一区二区三A片| 2024AV天堂手机在线观看| 国产SUV精品一区二区88L| 特黄做愛又硬又大A片视频 | 人与人和人与物XXX| 老女人熟女人妻国产| 最近最新中文字幕大全2018| 久久婷婷五月综合色情| 色拍拍在线精品视频| 性做爰A片免费视频A片直播| 亚洲欧美日本久久综合网站| 欧美一区二区视频在线观看| 日本私人一二三四区色欲| 亚洲在线2018最新无码| 好硬啊一进一得太深了A片69| 成人做爰WWW网站视频| 中文字幕亚洲精品久久AV| 亚洲.欧美.在线视频| 性做爰A片免费视频A片直播| 国产熟妇搡BBBB搡BB七区| 在线观看国产高清视频免费网站| 亚洲精品无码成人AAA片| 人人爽久久久噜噜噜丁香AV| 久久精品出轨人妻国产| 国产一区二区三区四区五在线观看| 国产免费无码又爽又刺激A片| 欧美成人看片一区二区三区尤物| 亚州免费A片无码区A片| 噼里啪啦免费观看高清动漫 | 午夜AV亚洲一码二中文字幕青青| 在线看片福利无码网址| 久久久无码精品成人A片小说| 嫩BBB槡BBBB搡BBBB| 最新国产精品好看的国产精品| 无遮无挡试看120秒高潮| 熟女肥臀白浆大屁股一区二区| 无码人妻欧美丰满熟妇区毛片| 国产乱子经典视频在线观看| 无码天堂亚洲国产AV久久 | 国产69精品久久久久久人妻精品| 最新亚洲国产手机在线| 无码欧美精品一区二区蜜桃色欲| 亚洲综合在线视频自拍| 无码专区久久综合久综合字幕| 韩国大尺度理伦片A片| 欧美一卡二卡三卡四卡免ios| 亚洲精品一区二区三区四区手机版| 国产无遮挡又黄又爽又色 | 女人与牲囗牲恔视频免费| 日本五十路有码中文中出| 久久精品国产免费中文| 亚洲一区二区无遮挡A片| 欧美又大又长又粗又爽A片 | 蜜臀久久99精品久久久久久小说| AV无码国产精品午夜A片 | 男人的天堂精品国产一区| 免费毛片a在线观看67194| 午夜色情影院色a国产| 九九热久久只有精品2| 精品无人区卡一卡二卡三| 在线看片福利无码网址| 国产精品久久久AV久久久| 国产亚洲精品成人AA片在线播| 成人亚洲A片V一区二区中出片| 中文字幕一区二区三A片| 欧美成人一区亚洲一区| 搡BBBB搡BBB搡18| 性妇WBBBB搡BBBB嗓小说| 97任你碰任你摸任你爽| 精品深夜AV无码一区二区老年| 国产乱子影视频上线免费观看| 亚洲成a人v欧美综合天堂下载| 性一交一乱一交A片久久四色| 高清不卡二卡三卡四卡免费 | 秋霞特色AA大片在线| 日韩大片在线永久免费观看网站| 1区2区3区4区产品在线线乱码| 水蜜桃一卡2卡3卡4卡| 国产高潮流白浆视频| 又硬又粗进去好爽A片免费视频| 日本猛少妇色XXXXX猛叫| 欧洲一卡2卡三卡4卡毛1| 国产精品爽爽久久久久久无码| 久久精品视在线观看85| 亚洲午夜视频在线观看| 欧美S码亚洲码精品M码| 黑人小伙内射中国女| 国内精品久久久久无码| 色欲人妻AV久久无码精品| 免费看一区无码无A片| 99国内偷揿国产精品人妻| 真人做爰高潮全过程毛片| 国产人妻人伦精品熟女A片| 韩国一区二区视频| 性色AV久久一区二区| 毛一卡二卡三卡免费看| 欧美精品久久99人妻无码| 4399 天天爱天天做| 又大又粗欧美黑人AAAAA片 | 中文字幕无码色情网| 欧美大码毛片在线播放| 五月久久丁香花婷婷欧洲| 丰满高潮大叫少妇| 女女女女BBBBBB毛片视频| 欧美人妻WWW无码国产黄漫| 成人乱码一卡二卡3卡| 中文精品卡1卡二卡3卡四卡| 成人在无码AV在线观看一| 国内精品久久久久久久试看 | 国产农村野战胖女人8毛片| 又湿又深又爽的A片视频| 国产美女无遮挡裸体免费视频软件| 成人全黄A片免费看| 欧美乱子YELLOWVIDEO| 最近免费中文字幕2018| 国产精品成人久久久久| 无码中文字幕无码一区日本| 精品1区2区3区产品乱码| 亚洲男人的天堂成人| 宅男午夜大片又黄又爽大片| 欧美jizzhd精品欧美满| 国产亚洲精品久久久999苍井空| 国产欧美成人一区二区A片| 欧美日韩无套内射另类| 亚洲中文无码永久免费| 婷婷97狠狠成人网站| 国产精品亚欧美一区二区三区| 久9视频这里只有精品试看| 日本三级人妻一级二级三级| 搡BBBB搡BBBB搡BBBB| 久久国产露脸老熟女| 亚洲情综合五月天| 欧美性猛交XXXXX拉换交大3| 国产成人午夜精品免费视频| 噼里啪啦免费观看高清动漫| 99在线在线视频观看| 久草原精品资源视频| 午夜免费无码福利视频麻豆| 狠狠色丁香婷婷久久综合| 黑人精品欧美一区二区蜜桃| 99爱在线精品视频免费观看9| 91精品无码一区二区| 国产精品久久久久久福利| 亚洲一区精品在线| 白天躁晚上躁天天躁2022| 高潮失禁喷水流白浆无码| 国产91无码精品秘入口| 国产高清色情在线观看APP| 男女激情无遮挡免费视频| 五月婷婷六月激情| 少妇高清精品毛片在线视频| 亚洲gogo人体大胆西西安徽| 亚洲精品成AV人片天堂无码| 免费国产一级一级内射| 成人无码区免费A片WWW| 朝鲜女子内射杂交BBW| 撕开奶罩揉吮奶头A片久久小说| 日韩精品免费在线观看| 巜锕锕锕锕锕锕好湿网站| 无敌影院视频在线播放 视频| 亚洲AV无码一区二区A片成人| 日本无吗无卡v二区| 免费无码一线A片AAA片| 性色AV久久一区二区| 色偷偷噜噜噜亚洲男人| 亚洲精品免费在线| 11孩岁女精品A片BBB| 久草原精品资源视频| 日本猛少妇色XXXXX猛叫| 成人三级做爰视频在线看| 国产人A片777777久久| 成人全黄A片免费看香港| 高潮无遮挡成人A片| 欧日韩无套内射变态| 午夜性啪啪A片免费AAA毛片| 两性午夜刺激爽爽视频| 狠狠色丁香久久婷婷综合图片| 麻花豆传媒剧国产入口| 成人网站网址在线观看播放| 久久久无码精品成人A片小说| 丰满少妇内射一区| 国产美女无遮挡裸体免费视频软件 | 国产高清资源一卡二卡| 无码精品人妻一区二区三A片| 好硬啊一进一得太深了A片69| 久久免费看少妇高潮A片特| 亚洲人大战欧洲人A片| 国产日韩欧美高清免费视频| 白白嫩嫩BBWBBWDI| 内射老妇女BBWXOGOD| 99久热这里精品免费| 天堂中文www资源在线| 国产av1插花菊综合网| 搡BBBB搡BBB搡五十| 国产又大又粗又猛又爽日本| 亚洲一区二区黄色| 久久精品麻豆日日躁夜夜躁妓女| 胸大美女又黄的网站| 国产又黄又爽又刺激的免费网址 | 亚洲精品一区中文字幕乱码| 四川少妇BBw搡BBBB槡BBBB蜜臀| 日本又色又爽又黄的A片18禁| 国产无遮挡A片又黄又爽软件| 被老外添嫩苞添高潮NP| 欧洲熟妇大荫蒂高潮A片视频| 亚洲精品久久久久中文字幕二区| 日日摸夜添夜夜夜添高潮| 国产成人无码免费看视频软件| 噼里啪啦免费高清看| 精品国产福利一区二区在线| 免费精品国产自产拍在线观看图片 | 大尺度激情做爰A片纯真时代| 国产啪亚洲欧美精品无码| 无码人妻深夜拍拍AAA片| 五月丁香婷婷天堂| 国产露脸无码A区久久| 床震吃奶摸下成人A片在线观看| 老牛嫩草AⅤ一区二区三区| 亚洲精品无码高潮喷水A片软件| 欲女熟妇国产一区二区| 内射中出无码护士在线| 国产成人无码免费看视频软件| 日韩亚洲欧美中文高清| AV国産精品毛片一区二区| k8欧美片黑人巨大| 无码免费一区二区三区动漫 | 欧美激情综合五月色丁香| 无套内射视频囯产| 国产精品人妻无码久久久豆腐| 永久免费看A片在线直播| 无码欧美精品一区二区蜜桃色欲 | 亚洲午夜无码毛片AV久久小说 | 久久成人做爰电影图片| 亚洲男人的天堂成人| 免费A片国产毛A片无码久久| 一女三黑人玩4P惨叫A片| 在线不卡日本v二区到六区| 国产人伦人妻精品一区| 午夜视频免费在线观看| GOGO人体做爰AAAA免费| 国产亚洲精品久久久久久禁果TV| 国产又爽又黄又不遮挡视频| 啦啦啦 中国 日本 免费观看| 另类少妇人与禽zOZZ0性伦| 国产成人av在线免播放观看| 66亚洲一卡2卡新区成片发布| 国产传媒18精品A片一区| 少妇被躁爽到呻吟喷水小说| 青青视频精品观看视频| 午夜精品白在线观看| 蜜臀AV色欲无码A片一区| 影音先锋中文字幕人妻| XXX2高清在线观看免费视频| 国产精品野外AV久久久| 国产午夜精品久久久久九九| 亲胸揉胸膜下刺激视频网站APP| 精品卡1卡二卡三卡乱码| 久久久久亚洲AV无码专区首护士| 国产黃色A片三級三級三級四川| 成年人黄色小视频| 玉女阁第一精品导航| 精品久久免费视频| 欧美国产精品久久久乱码| 国产69精品久久久久人妻刘玥| 国产精品久久久久久久久久久久| 国产熟妇无码一区二| 成人A片免费看男人社区| 无码免费人妻A片AAA毛| 一本一道AV一区二区三区| 青青草国产免费一区二区| 免费区大尺码体验区| 98无人区码一码二码三码软件| 国产免费人aa片片a片| 国产精品久久久久永久免费看| 亚洲精品无码成人A片在线漫画| 我要看WWW免费看插插视频| 国产做A爱片久久毛片A片秋霞| 日本A片色情AAA片WWW| 99久热这里精品免费| 亚洲一区二区在线老片| 日韩一区二区在线观看视频| 亚洲欧美人成无码苍井空| 少妇夹得好紧太爽了A片| 日韩一卡2卡3卡4卡乱码网站导航 亚洲国产欧美日本视频 | 免费AA片少妇人AA片直播| 日本一卡2卡3卡4卡免费观看| 97caoporn 免费视频| 精品视频在线免费观看| 国产亚洲精品A片久久久| 四LLL少妇BBBB槡BBBB| 国产精品XXXXX免费A片| 在线观看国产高清视频免费网站| 噜噜噜AV久久AV| 亚洲A片无码一区二区三区公司| 国产成人精品必看| 亚洲精品成人无码A片在线| 有叫声又超级污的视频| 搡BBBB搡BBB搡18| 久久久久亚洲Av无码专区桃色| 92久久精品一区二区| 我和嫲嫲狂躁了一晚上还住 | 乖乖女从小被C到大H补课1视频| 精产国品一二三产区M553| 丁香五月香婷婷五月| 久久AV无码乱码A片无码天美| 少妇无码太爽了不卡视频在线看| 在线最新av免费费观看| 成人视频在线视频| 成人午夜精品网站在线观看| 国产开女娃苞A片在线播放| 777片理伦片在线观看| 国产精品高潮呻吟AV久久动漫| 久久久无码A片观看免费 | 亚洲中文在线精品国产| 久热爱精品视频线路一| 永久免费无码AV国产网站| 中文字幕日本最新乱码视频| 国产精品人妻出轨| 在线观看的a站 最新| 李总灬大JI巴太粗太长了| 国产精品人妻无码久久久豆腐| 国产精品日韩欧美一区二区三区| 成人无码髙潮喷水A片| 日本少妇做爰免费视频网站| 海角社区最新 在线 观看| 亚洲AAAA片色欲aV| 亚洲一卡2卡3卡4卡乱码 在线| 四房播播婷婷基地| 伦理电影v男人天堂| 99国内偷揿国产精品人妻| 国产精品亚洲综合一区二区三区| 国产精品亚洲视频在线观看| 久久免费看少妇高潮A片特黄多| 无码免费人妻A片AAA毛| 60老熟女多次高潮露脸视频| 国产精品亚洲精品久久挡不住| 久久久亚洲精品一区二区三区| 成人无遮挡18禁免费视频| 国产欧美在线播放| 久久久视频2019爱| 潘金莲一级婬片AAAAAA播放| 98色精品视频在线| 丰满岳疯狂做爰2| 国产五级婬片A片免费| 午夜色情影院色a国产 | 男人天堂网2018最新地址| 阿v天堂2018在无码免费| 亚洲成人视频一区二区| 欧美成人无码午夜视频| 国精视频一卡二卡三卡四卡| 国产又粗又黄又爽的A片精华液| caoporn超碰发布页| 丰满人妻无码AV系列| 亚洲精品乱码8久久久久久日本| 国产麻豆MD传媒视频| 免费无码又爽又刺激A片| 成人无码区免费A片WWW| 黄A无码片内射无码视频| 中文字幕看片在线a免费| 一女被二男吃奶A片视频| 亚洲A片无码成人精品区| 玩弄丰满少妇高潮A片91| 国产精品美女乱子伦高| 五月色婷婷中文开心字幕| 中文精品卡1卡二卡3卡四卡| 欧美日韩免费播放一区二区| 在线看片av以及毛片| 尤物在线精品视频| 精品99卡1卡2卡3乱码| 免费乱理伦片在线观看夜| 黑人狂躁日本妞无码A片| 最近更新中文字幕免费完整版| 国产精品婷婷五月久久久久| 拔萝卜视频免费看高清| 亚洲国产一卡2卡3卡4卡5公司| 国产乱对白刺激视频| 国产亲子乱XXXXinin| 日本花心黑人hd捆绑| 小伙无套内射老女人| 精品日产一卡2卡三卡4卡三| 国精产品一码一码三mba| 国产日产欧产精品精品首页| 欧美精品狠狠色丁香婷婷| 丰满岳疯狂做爰2| 国产美女做爰A片免费| 中文新版资源WWW| 日韩亚洲欧美中文高清在线| 亚洲精品一区二区三区无码A片 | 亚洲精品久久久久77777| 中文字幕 欧美精品 第1页| 黑人强伦姧人妻日韩那庞大的| 中文字幕无码色情网| 噜噜噜AV在线观看| 精品老牛一卡2卡3卡4卡新版 | 亚洲日本在线天堂无码| 熟女人妻一区二区三区视频| 国产一卡2卡3卡四卡精品| 熟透的岳跟岳弄了69视频| 国内精品一卡二卡三卡| 亚洲AV国产精品色午夜洪2| 五月婷婷丁香花综合网| 国产69精品久久久久乱码韩国| 2019中文字字幕在线网站| 无忧传媒剧国产剧情MV在线| 男女生爽爽爽视频免费观看| 午夜少妇在线观看视频| 国产天美传媒一卡二卡| 爱我几何免费完整观看电影| 国产婷婷午夜无码A片| W无区码一码二码三码| 国产日产人成人A片AA| 在线天堂中文最新版www下载| 午夜激情在线观看| 色欲AV国产精品一区二区| 欧美黑人又粗又大高潮喷水| 亚洲乱码卡一卡二卡新区中国 | 精品国产乱码久久久久软件| 性XXXXX搡XXXXX搡景甜| 一级a爱视频免费久久| 性少妇mdms丰满hdfilm| 国产午夜免费视频片夜色| 色一情一乱一乱一区99AV白浆| 白丝高中生被C到爽哭视频| 人妻精品久久无码专区色视蜜臀| 国产黃色A片三級三級三級四川| 久久精品视频在线直播6| 少妇人妻人伦A片| WWW国产亚洲精品久久小说 | 人妻熟女一二三区夜夜爱| 精产国品一二三产区M553| A片爽爽爽爽爽爽爽爽爽| 人人爱夜夜爽日日做视频| 日日摸天天摸人人看| 亚洲综合AV色婷婷五月蜜臀 | 我学生的妈妈双字ID5| 无码人妻一区二区三区A片| 伊人婷婷六月狠狠狠去 | 国产精品人妻熟女a8198v久| 中文字幕日本无码少妇| 亚洲中文久久精品AV无码| 国产精品人妻无码免费A片导航 | 日本无码熟妇人妻在线视| 最近最新中文字幕大全手机| 亚洲AV国产精品无码精| 国精产品一码一码三mba| 色情A片成人免费看视频| 伊人婷婷涩六月丁香七月| 中文字幕无码人妻AAA片| 亚洲日本在线天堂无码| 国产成人久久婷婷精品流白浆| 欧美做爰猛烈动高潮视频| 91人妻人人澡人人爽人人精品投稿| 中文字幕色综合久久| 免费无码又黄又爽又刺激 | 精品国产一区二区三区久久影院| 亚洲欧洲中文日韩久久AV乱码| 日本国产精品无码字幕在线观看| 2018日韩朝吹一本到| jlzzzjizzzjlzzz亚洲| 丰满的女邻居在线观看| 黑人狂躁日本妞无码A片视频 | 大杳蕉中文在线看大杳| 黑人配亚洲女人ZOZO| 亚洲精品123区在线观看| 性一交一乱一交A片久久四色| 搡BBBB推BBBB推BBBB| 中文字幕亚洲综合小综合在线| 无人一码二码三码4码免费| 无码区国产区在线播放| 国产精品久久久久久无码五月蜜臂| 欧美精品狠狠色丁香婷婷| 五月婷婷丁香花综合网| 中文字幕专区高清在线观看| 亚洲一区日韩一区欧美一区a| JiZZJiZZ成熟丰满熟妇| 一区二区三区日韩免费播放| 中文天堂网WWW新版资源在线| 国产AV无码熟妇人妻麻豆| 99热久久是有精品首页| 最近最新中文字幕大全2018| 有叫声又超级污的视频| 欧美AAAA级A片又粗又硬| 国产精品成人观看视频免费| 国产真人性做爰久久网站| 无码成人一区二区三区入厕偷拍| 狠狠躁夜夜躁人人爽A片| 97人妻成人免费视频| 国产清纯粉嫩初高生色情软件| 国产97色在线 |日韩| 麻豆一二三四区乱码| 少妇被粗大的猛烈进出A片久久久| 亚洲欧美日韩中字视频三区 | 精品一卡2卡三卡4卡免费乱码| 王局长把乳罩解开吃胸的动态图| 国产午夜精品一区二区三区四区| 神马影院夜伦鲁鲁片| 人妻激情综合久久久久| 国产又黄又爽胸又大免费视频| 农村少妇WWWCOM| 99精品国产乱码久久久人妻| 好想被狂躁A片免费无码| 偷录到真实的叫床声视频| 免费观看欧美成人AA片爱我多深| 国精品无码一区二区三区在线A片| 久久久无码人妻精品无码| 亚洲精品久久久久中文字幕二区| 国产精品无码免费在线| 色婷婷AV久久久久久久 | 91人妻人人澡人人爽人人精品投稿| 香蕉噜噜噜噜私人影院| 久久久久亚洲Av无码专区桃色| 久久久久综合网久久| 国产五月色婷婷六月丁香视频| 日本卡二卡三卡四卡免费网址| 又大又粗又爽免费视频A片| 夜夜穞天天穞狠狠穞AV美女按摩| 久久精品久久久久| 国产目拍亚洲精品一区二区三区| 亚洲视频一区在线| 成人在免费视频手机观看网站| 最近更新中文字幕免费完整版 | AA片免费观看视频中国| 精品国产一区二区三区久久影院| 欧亚乱熟女一区二区三区在线| 亚洲精品国产第一区第二区| 久久久日韩精品一区二区| 亚洲最大的色情网COM| 亚洲精品久久久久久中文| 狠狠色很很鲁在线视频| 国产人妻一区二区免费AV| 欧美黑人添添高潮A片WWW| 曰本无码人妻丰满熟妇5G影院| 欧美顶级A片狂欢| 亚洲精品无码高潮喷水A片在线| 国产色情18一20岁片A片下载| 狠狠躁日日躁夜夜躁A片免费| 国产一区二区三区国产精品| 阿v2019天堂官网| 久久中文字幕无码A片不卡| 成人午夜精品网站在线观看| 男女野外做爰全过程69影院| 国产AA久久大片日本无码| 欧美jizzhd精品欧美满| 久久精品久久久久| 久久国产欧美日韩精品免费| 一线免费视频BD高清| 亚洲精品综合五月久久小说| 国产精品A一区二区三区腾讯导航| 无码精品一区二区三区在线A片| 欧美成人国产一区二区| 成人日韩熟女高清视频一区| 亚洲一卡二卡三卡四卡无卡网站 | 欧美日韩亚洲一区二区三区在线观看 | 亚洲国产精品久久又爽黄A片| 亚洲AV国产精品无码三区在线看| 国产精品成人观看视频免费| 亚洲一卡二新区乱码绿踪林| 国产精品视频在线观看| 精品亚洲国产成人A片在线播放| 亚洲成色A片77777在线麻豆| 亚洲国产精品成人精品A片| 国产情侣2020免费视频| 国产人妻大战黑人20P | 永久免费看A片无码精品| 成人做爰WWW网站视频| 99久久做夜夜爱天天做精品| 一区三区在线专区在线| 蜜桃AV色偷偷AV老熟女| 亚洲精品一线二线三线无人区| 五月婷婷开心中文字幕| 亚洲 欧洲 日韩 综合在线| 亚洲精品国产成人无码区A片| 国产白嫩护士在线播放| 亚洲视频无码高清在线| 按摩高潮A片一区二区三区| 日产一线二线三线哺乳| 国产精品AV色欲蜜臀在线| 亲胸揉胸膜下刺激娇喘免费视频| 丰满少妇猛烈进入A片K8经典| 免费精品美女久久久久久久久 | 日韩免费A片奶头| XX性欧美肥妇精品久久久久| 日韩插啊免费视频在线观看| 国产精品久久久久久久免费A片| 色情无码鲁鲁A的电影| 久久免费看少妇高潮A片特无毒| 伊人大香焦手机在钱视| 波多久久亚洲精品AV无码| 东北富婆25分钟对白| 国产在线看片免费视频 | 色情无码鲁鲁A的电影| 最近最新中文字幕大全高清8| 最爽最刺激18禁视频| 亚洲天堂2017手机在线| 久久AV无码乱码A片无码蜜桃| 欧美乱妇日本无乱码特黄大片| 国产亚洲精品久久7788| 国产一性一交一伦一A片小说| 悟空影视免费观看视频| 国产又黄又刺激的A片小说| 日本无卡有线v四区| 少妇性BBB搡BBB爽爽爽视頻| 久久久精品免费视频| 在线精品国精品国产不卡| 成人亚洲A片V二区三区久久 | 教室停电H嗯啊好硬好湿攻守| 51久章草在线视频| 人妻互换AV无码打压3p| 久久天天躁狠狠躁夜夜AVAPP | 日产乱码卡2卡三卡四视频免费 | 午夜天堂成人欧美www无码| 日日摸夜夜添夜夜添高潮免费A片 97国产精华最好的产品久久久 | 亚洲精品成人无码一区二区三区| 东北熟妇高潮30分钟| 国产精品 同事 在线 视频| 中文字幕欧美一区| 国产精品69白浆在线观看免费| 欧美又黄又大又爽A片| 人妻熟女狠狠涩蜜桃| 一点都不卡的中文视频| 好硬啊一进一得太深了A片69| 日本A片色情AAA片WWW| 亚洲AV又黄又爽超级A片软件| 欧美内射成人无尺码免费视频| 国产亚洲精品久久久久久久| 花蝴蝶免费高清视频中国| 乱码精品一卡2卡二卡三| 国产精品久久久久久日本一道| 亚洲AV成人片色在线观看高潮 | 性色AV一区二区三区咪爱四虎| 琪琪电影午夜理论片YY6080| 萌白酱17分钟视频| 国产一卡2卡3卡4卡2021免费观看 69精品国产久热在线观看 | 精品深夜AV无码一区二区老年| 全黄做爰100分钟视频| 欧美黑人猛猛猛| 萌白酱17分钟视频| 中文字幕一区中文亚洲| 精品国产乱码久久久久久免费| 国产麻豆剧传媒AV国产图片| 亚洲精品成人AA片在线播| 中文精品一区二区三区四区 | 另类少妇人与禽zOZZ0性伦| 富婆偷人对白在线观看| 国产成人精品久久一区二区三区 | 国产精品人妻熟女a8198v久| 摸添揉捏胸还添下面视频| 海角社区最新在线播放| 日韩精品无码一区二区免费A片 | 欧美又粗又黄又硬的A片| 久久中文字幕无码A片不卡| 91日本在线观看亚洲精品| 玩弄丰满少妇高潮A片91| cao死你小sao货湿透了| 国产无遮挡A片无码免费| 丰满人妻无码AV系列| 激情区小说区偷拍区图片区| 在办公室里揉弄小雪好爽| 国产亚洲精品久久久久5区| 黑人猛交一二三区A片R| WW含羞草传媒在线观看| 国产精品看高国产精品不卡| 好吊妞无缓冲视频观看| 中文字幕日本最新乱码视频| 国产成人av在线免播放观看| 亚洲精品久久久中文字幕痴女 | 免费无码片AV在线观看 | 色琪琪av男人的天堂| 黄页网站18以下勿看| 欧美乱妇乱码大黄AA片| 四虎影视最新入口是多少| WWW亚洲精品久久久| 色欲AV蜜臀AV在线观看麻豆| 日本乱码卡1卡2卡三卡重新| 婷婷伊人綜合亞洲綜合網| 久久AV无码乱码A片无码| 免费看国产成年无码A片| 国产午夜免费视频片夜色| 91人妻人人操人人爽人人精品| 91久久精品国产亚洲| 日本久久精品视频| 国产成人午夜精品5599| 亚洲精品久久久WWW| 久久久久综合网久久| 色一情一乱一乱一区99AV| 美女校花被调教出奶水| 三男挺进一女爽爽爽小说| 亚洲欧美日韩中字视频三区| 亚洲精品国产综合AV在线观看| 日韩MV欧美MV中文无码| 国产成人精品视频VA片| 欧美freesex交免费视频| 亚洲精品区无码欧美日韩| 欧美丰满大乳无码少妇| 亚洲一区二区三区四区五区六| 噜噜噜AV在线观看| 成人免费120分钟啪啪| 亚洲精品久久久久久久爆乳电影| 蜜桃AV色欲A片精品一区| 日韩一级特黄毛片在线看| 欧美性猛交AAAA片黑人| 国产人妻人伦精品98| 欧美午夜艳片欧美精品| 国产亚洲精品AAAA片APP| 亚洲日韩精品射精日| 一区二区乱子伦在线播放| 午夜妇女AAAA区片| caoporn国产精品免费视频| 蜜臀久久99精品久久久久久小说| 婷婷开心情五月色在线| 一级a爱视频免费久久| 刺激妇乱子伦真实故事| 欧洲精品卡1区2卡三卡四卡| 无遮挡BBBBB级A片| chinese山东猛1猛video69| 国产AV熟妇人震精品一品二区| 国产亚洲精品成人AA片| 人妻激情综合久久久久| 久久无码AV亚洲精品色午夜麻豆| 日本一区二区三区免费A片| 粉嫩入口处粗黑进进出出BL| 久久久久亚洲Av无码专区桃色| 乱码精品一卡2卡二卡三| 亚洲AV怡红院AV男人的天堂 | 国产亚洲精品久久久久久一区二区| 国产精品人妻一区夜夜爱| 一品二品三品中文字幕| 日韩母与子免费A片| 午夜伦理不卡片2018在线| 无码AV免费精品一区二区三区| 国产精品无码久久久久2028| 欧美又粗又长又大AAAA片| 最近2018免费中文字幕1页| 午夜视频一区二区三区| 国产人妻性生交大片| 性做爰A片免费视频| 久久婷婷五月综合色情| 亚洲精品一区无码A片| 性色AV一区二区三区咪爱四虎| 国产黃色A片三級三級三級四川 | 成在人线A片无码免费网址1| 欧美日韩精品人妻狠狠躁免费视频| 久热在线这里只有精品7| 男女做爰猛烈吃奶摸大胸| 国产一卡 二卡三卡四卡无卡乱码视频| 亚洲精品久久蜜臀AV色欲 | 99国产在线视频有精品视频| 亚洲AV无码无限在线观看不卡| 亚洲精品无码一二区A片| 久久精品亚洲成在人线AV麻豆| 精品日产一卡二卡四卡| 韩国床震无遮挡的视频| 含羞草免费观看视频2019| 日本妇人成熟免费中文字幕 | 特黄A又粗又大又黄又爽A片软件| 东北农村小伙GAY与老大爷| 国产成人精品男人的天堂网站 | 神马影院夜伦鲁鲁片 | 办公室强奷漂亮少妇视频| 色欲AV久久一区二区| 欧美性猛交99久久久久99按摩| 亚洲卡2卡3卡4卡精品| 免费视频网站在线观看黄| 欧美日本国产VA高清CABAL| 欧美午夜特黄AAAAAA片| va亚洲va天堂va视频在线| 免费看成人A片无码视频网站| 日本A片中文字幕精华液| 中文字幕欧美一区| 国产一卡2卡三卡4卡免费网站| 爱我几何免费完整观看电影| 在线观看黄A片免费AV软件| 免免费国产AAAAA片| 午夜人妻无码一区二区三区蜜桃视频 | 国产成熟妇人高潮A片| 乱码一卡2卡3卡4卡精品| 欧美又大又黄又粗又长A片| 亚洲A片无码精品毛片| 欧美又长又大又深又爽A片特黄| 国产99视频在线观看| 乱短篇艳辣500篇H文| 91在线无码秘 入口在线| 91一区二区三区四区五区| 欧美jizz40性欧美| 亚洲精品无码高潮喷水A片在线| 欧美精品A片XXX| cao死你小sao货湿透了| 在线观看国产高清视频免费网站| 日产乱码二卡三卡四卡视频播放 | 一线免费视频BD高清| 欲女熟妇国产一区二区| 日本高清2018字幕| 中日韩无一线二线三线| 狠狠躁夜夜躁人人爽A片| 一个色综合国产色综合| 2019久久视频国产| 欧美阿v天堂视频在99线| 亚州精品久久久久久久久| “ 内射 ” 的搜索结果| 加勒比AV一本大道香蕉大在线 | 国内精品乱码卡1卡2卡3免费| 精品成品国色天香卡一卡MBA | 国产亚洲色婷婷久久99精品男同| 日日摸夜夜添夜夜添高潮免费A片 97国产精华最好的产品久久久 | 好大好爽好深舒服死了A片| 久久AV无码乱码A片无码蜜桃| 日日鲁鲁鲁夜夜爽爽狠狠| 国产人妻人伦精品98| 亚洲精品久久无码AV片WWW| 国产97精品无码A片在线看密| 国产日韩成人内射视频| 亚洲男人97色综合久久久| 色噜噜噜亚洲男人的天堂| 无码一卡二卡三卡四卡视频版 | 精品国产91久久久久久浪潮蜜月| 午夜福到在线2019| 美丽姑娘高清版在线电影| 91无码人妻精品国产色情竹菊影视| 久久久国产精品免费A片分天美| 色欲AV午夜精品AV| 中文字幕无码色情网| 青青草成人免费现看| 久久视频这只精品99re6| 无套内谢少妇毛片AAAA片免费 | 久久91精品国产91久久户 | 国产乱码1卡二卡3卡四卡| 护士张开腿被奷日出白浆| 日本亚洲中文字幕无码区| 成人做爰片免费网站| 亚洲精品久久久久久久久AV无码| 刺激成人在线视频观看| 四个熟妇搡BBBB搡BBBB| 欧洲5卡6卡7卡老狼在线| 亚洲在线一人香蕉免| 亚洲AV无码一区二区三区乱子伦 | 女人与牲囗牲恔视频免费| 国产成人午夜精品5599| 美熟丰满老妇女bbw| 午夜视频免费在线观看| 免费国产美女爽到喷出水来视频 | 日韩欧美群交P片內射中文| 四虎影视最新入口是多少| 高清国产MV视频在线观看| 亚洲一区二区在线老片| 午夜福利1000集80 视频| 欧美两女被1男所奸1级性爱大黄片 | 男女做爰猛烈啪啪吃奶动A | 乱码精品一卡二卡无卡| 精品一区二区三区在线成人| 无码区国产区在线播放| 色情毛片AAAAAA片毛片| 国产又黄又刺激的免费A片小说| 亚州免费A片无码区A片| 内射白嫩少妇超碰| 丁香花在线电影小说观看| 日韩视频在线精品视频免费观看| 国产做A爰片久久毛片A片软件| 在线中文天堂最新版官网| 色欲AV亚洲永久无码精品| 91在线无码秘 入口在线| 校草SAO货撅起屁股扒男男| 搡BBBB搡BBB搡五十| 日日摸天天摸人人看| 国产亚洲精品久久无亚洲| 国产乱妇无乱码大黄AA片| 一本一道AV一区二区三区| 国产欧美日韩另类精彩视频| 日本少妇BBW丰满做爰图片 | 日韩一区二区免费视频| 国产免费人aa片片a片| 亚洲AV综合色情区一区| 国产真实乱人偷精品人妻图| 我和嫲嫲狂躁了一晚上还住| 丰满熟妇大号BBWBBWBBW| 奇米影视7777久久精品人人爽| 男人大JI巴做爰视频D2| 久久视频在线视频观看99| 国色天香一卡2卡三卡4卡在线| 无码免费人妻A片AAA毛片一区| 欧美又大又长又粗又爽A片| 黑人强伦姧人妻日韩那庞大的| 国产精品久久免费视频| 青草草97久热精品视频| 国产高清色情在线观看APP| 国产精品亚洲精品久久品| 国产成人精品一区二区免费| 久久久久综合网久久| 国产精品视频在线观看| 无码视频在线观看| 国产啪亚洲欧美精品无码| 性色AV久久一区二区| 精品无码乱码AV| 日本添下边无码视频| 国产做A爱片久久毛片A片秋霞| 久久亚洲精品无码A片大香大香| 欧美人与性动交α欧美精品| 蜜臀久久99精品久久久久久小说| 久久精品中文騷妇女内射| 97丨九色丨国产人妻熟女| 巜锕锕锕锕锕锕好湿网站| 亚洲日本欧美日韩中文字幕| 国产亚洲国际精品福利| 国产成人精品无缓存在线播放| 无码射肉在线播放视频| 婷婷开心情五月色在线| WWW亚洲精品久久久| 邻居少妇被爽到高潮A片| 国产一性一交一伦一A片小说| 极品人妻VIDEOSSS人妻| 男女做爰猛烈吃奶摸大胸| 欧美jizz40性欧美| 在线免费黄色鲁喷少妇诱惑| 欧美又黑又大AAA毛片| 熟女无套内射线观56| 午夜黄色视频高清无码 | 国产婷婷午夜精品无码A片| 亚洲精品久久久无码| 国产一卡三卡四卡无卡精品| 亚洲在线中文字幕2| 午夜福利0855免费视频| 亚洲精品123区在线观看| 国产精品久久久久9999小说| 亚洲欧美国产双大乳头| caoprom最新超碰地址| 91无码人妻精品国产色情竹菊影视| 四川少扫搡BBW搡BBBB| 开心五月丁香花综合网| 2017亚洲天堂最新地址| 成人在免费视频手机观看网站| 国产又黄又刺激的A片小说| 免费观看欧美日韩亚洲| 特级太黄A片免费播放成人片视频| 影音先锋av色噜噜影院| 亚洲综合AV在线在线播放| 99国产精品久久久久久久日本竹| 又大又粗成人A片免费看| 蜜臀亚洲AV永久无码精品老司机| 精品一卡二卡三卡四卡网站| 国精产品一码一码三mba| 女人高潮抽搐AAA| 日产精品卡1卡2卡三卡在线| 国产永久精品大片wwwApp| 男人在天堂a视频| 国产亚洲午夜精品a一区二区| 无遮挡BBBBB级A片| “ 内射 ” 的搜索结果| 欧美jizzhd精品欧美满| 国产成人精品午夜福利在线播放| 色情毛片AAAAAA片毛片| 国产人成无码视频在线观看| 国产亚洲精品久久久久久一区二区| 特黄AAAAAAA片免费视频| 国产精品久久久久久搜索| 欧美激情AAAA片免费视频| 姝姝的白丝又湿又紧| 日本少妇做爰免费视频网站| 天堂网WWW最新版| 国产亚洲精品AAAAAAA片| 无码丰满人妻熟妇区| 国产又粗又猛又爽又黄A片漫| AV97最新无码喷水叫床| 伊人亚洲AV久久无码精品 | 国产又爽又大又黄A片美女裸体| 午夜精品白在线观看| 日本人妻仑乱少妇A级毛片一| 玫久热这里只有精品2| 欧美黑人性受XXXX精品| 91无码人妻精品国产色情竹菊影视| 欧美激情无码成人A片| 精品国产久线观看视频| 国色天香一卡2卡三卡4卡在线| 老司机无码精品A| 99在线精品国自产拍不卡| 日本妇人一成熟A片高潮| 日本无码AAA区A片视频| 亚洲一区二区黄色| 无码欧美精品一区二区蜜桃色欲| 高清欧美一区二区三区| 精品AV一区二区三区久久| 欧美日韩中文国产一区| 大学生做爰全过程免费的视频| “顶XX”“街X”“痴汉XXX| 精品AV中文字幕在线毛片| 欧美做爰猛烈大尺度老电影| 人禽无码做爰在线观看视频| 国产人A片在线乱码视频| 最新无码国产在线视频xyz| 国产乱码1卡二卡3卡四卡5| 无码人妻毛片丰满熟妇区毛片国产| 精品无码一区二区的天堂| 日本无码欧美激情在线视频| 国产目拍亚洲精品一区二区三区| 国产精品高潮呻吟久久影视A片| 亚洲精品久久久久久中文| 日产精品一卡2卡三卡四| 亚洲精品久久久久久AV伊人| 最好看的最新的中文字幕资源 | 成在人线av无码A片试看| 色婷婷亚洲婷婷7月| 日韩精品卡1卡二卡3卡四卡| 奇米影视第四色av首页| 午夜少妇在线观看视频| 亚洲不卡一卡2卡三卡4卡5卡| 性色AV久久一区二区| 99在线这精品视频| 人妻仑乱A片免费| AV无码国产精品午夜A片| 男人大JI巴做爰视频D2| 五月婷婷丁香花综合网| 国产又爽又大又黄A片美女裸体| 午夜福利国产在线观看1| 最新版天堂网WWW| 国产又粗又猛又爽的视频A片| 人妻夜夜爽爽88888视频| 丰满熟妇大号BBWBBWBBW| 亚洲综合色五月久久婷婷| 最近最新中文字幕大全高清8| 婷婷伊人五月尤物| 日产免费一二三四区禁止转发传播| 91麻豆精品A片国产在线观看 | 国产乱码二卡3卡四卡| 色国产在线视频一区| 色偷偷的xxxx8888| 浪货嗯啊趴下NP粗口黄暴| 搡女人真爽免费视频网站| 欧美躁天天躁无码中文字| 日韩电影在线播放| 欲女熟妇国产一区二区| 亚洲A片无码精品毛片色戒| 中文字幕欧美日韩VA免费视频| 少妇邻居做爰2伦理| 东北熟妇高潮30分钟| 亚洲精品一区二区三区精品 | 亚洲中文超碰中文字幕| 中文字幕 欧美精品 第1页| 国产精品乱码久久久久久软件 | 丁香花在线电影小说观看| 精品国产天堂综合一区在线| 日产乱码卡一卡免费| 边啃奶头边躁狠狠躁A片动漫| 777午夜福利理伦电影网| 亚州精品久久久久久久久| 爱我几何完整版在线观看| 人妻仑乱少妇A片| 欧美亚洲精品一区二三区8V| 噼里啪啦电影在线观看免费| 久久久无码精品亚洲A片猫咪| 少妇被粗大的猛烈进出A片久久久| 亚洲va在线va天堂va手机| 91在线无码秘 入口在线| 花蝴蝶免费高清视频中国| 少妇被多人C夜夜爽爽| 少妇被狂躁爽一区二区| 狠狠躁18三区二区一区传媒剧情| 日韩视频在线精品视频免费观看 | 欧美激情A片一区二三区| 日产免费一二三四区禁止转发传播 | 国产寡妇乱子伦一区二区三区。| 又硬又粗进去好爽A片欧美| 亚洲成年网站在线观看| 麻豆精品一区二区三区Av沈娜娜| 亚洲精品一区二区无码夜色| 日本一区午夜爱爱| 欧美肥老太WBWBWBB| 91一区二区三区四区五区| 国产69精品久久久久久人妻精品| 新妺妺窝人体色WWW| 欧美又粗又大AAA片| 窝窝午夜理论片影院| 亚洲午夜精品A片久久WWW软件 | 中文字幕在线看成电影乱码| 在线 国产 欧美 亚洲 天堂| 亚洲欧美日韩在线观看一区二区三区 | 午夜尤物禁止18点击进入| 国产乱人偷精品人妻A片| 日韩内射美女片在线观看网站| 国产亚洲精品久久久久秋霞不卡| 琪琪午夜伦伦A片| 精品国产乱码久久久久久1区2区-亚洲 | 国产成人无码精品久久久性色| 亚洲精品久久久久久久久久久| 少妇饥渴无码高潮A片爽爽小说| 国产精品亚洲综合一区二区三区| 琪琪午夜福利免费院| 日本人妻仑乱少妇A级毛片一 | A级无遮挡超级高清-在线观看| 成人A片熟女人妻久久| 亚洲精品久久99久久一二三区| 成人亚洲A片V一区二区三区婷婷 | 97人妻在线公开视频在线观看| 黄页网站18以下勿看免费| 亚洲 素人 字幕 在线 最新| 久久免费手机视频| 巜人妻公激情の日本| 天堂网在线新版WWW| 永久免费看A片无码精品| 青青青爽在线视频观看| 拍真实国产伦偷精品| 爱我几何无删除原版在哪看| 风韵丰满熟妇啪啪区老老熟女百度| 日产乱码一二三区别免费仙踪林| 欧美日韩精品一区二区三区高清视频| 一区二区三区无码高清视频| 最近更新中文字幕在线2018二| av小四郎收藏家网站| 国产欧美日韩视频免费| 国产又黄又刺激的A片小说| 国产成人夜色影视视频| 国产精品久久久久久久久99热| 亚州国产AV一区二区三区伊在| 高潮失禁喷水流白浆无码| 成人亚洲A片V一区二区三区日本| 久久精品国产AV一区二区三区| 亚洲精品一区无码A片| 欧洲一卡二卡三卡| 色情大尺度吃奶做爰| 按摩高潮A片一区二区三区| 无码人妻精品中文字幕| 久久精品国产男包| 久久综合亚洲精品一区二区| 日本国产精品无码字幕在线观看 | 日韩欧美激情兽交| 全黄做爰100分钟视频| 久久精品国产精品| 婷婷开心情五月色在线| 免费一级做a爰片久久毛片潮喷| 丁香花在线视频观看免费| 国产午夜成人AV在线播放| 草莓视频午夜在线观影| 男女做爰猛烈吃奶摸大胸| 欧美熟妇乱人伦A片免费高清| XXX2高清在线观看免费视频| 亚洲AV嫩草AV极品A片| 久久er热这里只有精品23| 在办公室里揉弄小雪好爽| 人人爱夜夜爽日日做视频| 麻花豆剧国产MV在视频播出| 亚洲精品成AV人片天堂无码| 丰满的子3中文电影| 无码毛片内射白浆视频| 成人午夜精品网站在线观看| 国内精品久久久久久网站| 国产又粗又长又硬又猛A片| 69久久夜色精品国产69女警官| 日韩免费A片奶头| 欧洲色情三级欧美三级视频| 99国精产品一区二区三区A片| 久久久久久久国产免费看| 4399 天天爱天天做| 亚洲精品色情婷婷在线播放| 拍真实国产伦偷精品| 中文字幕一区二区三A片| 国产午夜高潮熟女精品AV| 免费国产美女爽到喷出水来视频| 国产人妻一区二区免费AV| 女人被添全过程A片久久AV| 亚洲精品一区二区三区四区五区| 国产精品亚洲精品久久久久| 国产人妻大战黑人20P| 伊人大杳蕉在线影院在线播放| 最近免费中文字幕2018 | 亚洲精品1卡2卡三卡4卡乱码 | 国产在线一区二区三区四区| 性色AV一区二区三区咪爱四虎| 特级A欧美做爰AAAAA片| 免费观看www成人A片| 国产亚洲色婷婷久久99精品男同 | 熟女人妻-蜜臀AV-首页| 人妻精品久久无码专区色视蜜臀| 五月丁香激色婷五月天| 朝鲜女子内射杂交BBW| 亚洲一区二区无遮挡A片| 欧洲丰满大乳人妻无码欧美| 欧美精品无码久久久潘金莲| 娇BBB搡BBBB揉BBBB| 午夜免费观看_视频在线观看| 亚洲AV国产精品无码A片| 免费看少妇高潮A片黄| 日韩一区二区三区视频在线观看| 无码人妻丰满熟妇啪啪网不卡| 国产精品A久久久久久久久| 久久亚洲99精品无码中出| 女人与牲囗牲恔视频免费| 少妇呻吟白浆高潮啪啪69| 亚洲无码免费高清视频| 99国产精品久久久久久久日本竹| 亚洲一卡2卡3卡4卡精| 亚洲精品免费在线| 亚洲一区在线观看无码欧美| 国产精品久久人妻无码A片| 午夜成人性爽爽免费视频| 无码人妻精品中文字幕| 久久亚洲精品无码A片大香大香| 亚洲欭美日韩颜射在线二| WWW夜片内射视频在观看视频 | 婷婷丁香五月激情综合站| 内射中出无码护士在线| 久久视频在线视频观看精品15| 成人污污视频在线观看| 老富婆全程露脸在线观看| 欧美日韩一区二区三区四区| 乱码一二三四视频不卡| 欧洲一卡2卡三卡4卡毛1| 国产亚洲精品久久久久秋霞| 亚洲字幕AV一区二区三区四区| 熟妇人妻中文字幕无码老熟妇| 亲子乱AⅤ一区二区三区的| 最近2018年中文字幕大全视频| 美女翘臀强进入系列在线观看| 国产激情久久久久久一级A片老师| 老女人熟女人妻国产| 人妻性奴波多野结衣无码| 国产超碰AV人人做人人爽| 亚洲国产精品成人精品A片| www国产亚洲精品久久网站| 丰满少妇被猛烈进出69影院 | 少妇做爰喷水高潮呻吟A片免费 | 精品国产一区二区三区四区在线看| 欧美精品一区二区蜜臀亚洲| 午夜精品久久久久久久爽| 啊轻点内射在线视频| 五月丁香啪啪激情综合5109| 国产精品.XX视频.XXTV| 国产日韩欧美高清免费视频| COM忘忧草WWW日本污污黄| 1区2区3区4区产品在线线乱码| 精品国产乱码久久久久软件| 久久人妻无码毛片A片涩天使| 日本熟妇人妻另类无码| 噼里啪啦免费高清看| 中文字幕精品AV乱码在线| 狠狠色丁香久久婷婷综合图片| 中文文字幕文字幕亚洲色| 国产亚洲精品久久久久久老妇小说| 欧美人做人爱A全程免费| 悟空影视免费观看视频| 国产卡二卡三卡四卡免费网址| 国产免费无码又爽又刺激A片小说| 亚欧人妻精品AV熟女人妻| 国产精品毛片AV在线看| 2019中文字字幕在线网站| 国产亚洲精品久久7777777| 亚洲精品久久久久久动漫器材一区| 亚洲一区二区黄色| 亚洲精品久久一区二区三区四区 | 国产精品人妻一码二码| 先锋影音avt天堂影院| 男人强撕开奶罩揉捏我奶头视频| 果冻传媒国产仙踪林| 天堂网资源中文最新版| 在线看片免费观看视频| 韩国一区二区视频| 日本VA欧美VA精品发布| 亚洲乱熟乱熟女一区二区| 国产亚洲色婷婷久久99精品男同 | 国产麻豆成人传媒免费观看| 色欲一区二区三区精品A片| 无码AV亚洲一区二区毛片| 久久精品国产久精国产果冻传媒| 亚洲50熟女性视频免费| 日韩一区二区三区视频在线观看| 成人永久免费视频网站APP| 国产熟妇精品一区二区| 日韩无码一区二区三区四区| 亚洲熟少妇在线播放999| 亚洲精品国产不卡在线观看| 久热在线这里只有精品7 | 少妇性BBB搡BBB爽爽爽小说| 在线欧美精品一区二区三区| 98久久人妻少妇激情啪啪| 国产精品亚洲二线在线播放| 欧美人牲交A欧美精区日韩| 成年美女黄网站色大免费全看| 韩日午夜在线资源一区二区| 日本熟妇乱人伦A片精品软件| 免费又黄又爽A片免费看漫画| 亚洲精品爆乳一区二区H| 无码免费一区二区三区动漫| 亚洲AV无码一区二区三区乱子伦 | 最近最新中文字幕大全手机| 伊人婷婷涩六月丁香七月| 亲胸摸下面激烈免费网站| 手机午夜电影神马久久| 日韩视频在线精品视频免费观看| 少妇做爰免费视频了| 高清无码午夜福利在线观看| 亚洲A片无码精品毛片| 久久亚洲精品国产露脸| 国产精品久久欧美一区| 色情毛片AAAAAA片毛片| 亚洲男人的天堂成人| 亚洲国产精品成人无码A片软件| 亚洲AV成人噜噜无码网站A片 | 国产真实乱人偷精品人妻图| 秋霞无码AV久久久精品| 1000部毛片A片免费观看| 亚洲一区二区无遮挡A片| 韩国无码又爽又刺激的A片| 海角社区在线视频播放观看| 亚洲 日韩经典 中文字幕| 成人欧美一区二区三区A片| 动漫在线播放的A站本免费 | 亚洲精品国产不卡在线观看| 姝姝的白丝又湿又紧| 国产精品JIZZ在线观看A片| 曰本一道本久久88不卡| 亚洲精品拍拍央视网出文| 激情偷乱人伦在线视频| 亚洲男人天堂2018av| 久久久精品免费视频| 国产啪亚洲欧美精品无码| 最近更新中文字幕在线2018二| 无码高潮又爽又黄A片软件| 丁香五月亚洲春色| 中文字幕亚洲一区| 国产精品XXXXX免费A片| 日本高清2018字幕| 两性午夜刺激爽爽视频 | 国内精品美女视频免费直播| 欧亚乱熟女一区二区三区在线| 好吊妞无缓冲视频观看| 亚洲精品中文一区二区在线| 亚洲精品中文幕一区二区| 特级做A爰片久久毛片A片喷水 | 久久精品免费人成人A片| 日本无码免费久久久精品| 丰满岳疯狂做爰2| 国产精品AV无码毛片久久| 国产亚洲精品久久久久久鸭绿欲 | 亚洲国产中文在线视频| 亚洲AV久久无码精品九九软件| 成人午夜精品网站在线观看| 亚洲精品色情婷婷在线播放| 人妻精品久久无码专区色视蜜臀| 做爰高潮A片视频35分钟| 国产精品成人观看视频免费| 日本少妇BBW丰满做爰| 2022一本久道久久综合狂躁| 国产又爽又猛又粗的视频A片 | 日本又色又爽又黄的A片视频免费| 青青草免费线看v伊人| 女邻居夹的太紧太爽了A片| 玉女阁第一精品导航| 噜噜噜AV久久AV| 99久久精品免费看国产一区二区| 久久久久亚洲视频| 久久AV亚洲精品一区无码网| 国语激情对白 VIDEOS | 成人婷婷网色偷偷亚洲男人的天堂| 国产成人午夜精品5599| 国产久热在线观看视频 | 精品国产一区二区三区久久影院 | 男人躁女人到高潮AV| 国产传媒免费看A片| 韩国一区二区视频| 无码人妻精品中文字幕| 99久久久无码国产精品免费砚床| 四虎最新地址通知www| 一色桃子中文字幕人妻熟女作品| 久久久无码精品亚洲A片0000| 国产无遮挡A片无码免费| 特级做A爰片久久毛片A片喷水| 国产精品看高国产精品不卡| 久久成人麻豆午夜电影| 丁香六月久久婷婷开心| 日本又黄又爽又色又刺激的视频| 日本人妻伦在线中文字幕| 成人午夜AV亚洲精品无码网站| 久久久国产精品免费A片芒果| 少妇被粗大的猛烈进出A片久久久| 国产精品日本不卡一区二区| 国产高清乱理伦片| 国内精品久久久久无码| 无码破解日韩AV无码| 欧美射精网站下载含羞草| 丁香花视频免费播放社区| 拍真实国产伦偷精品 | 国产18在线观看17c| 黑人小伙内射中国女| 日韩好精品视频你懂的| 久久免费看少妇高潮A片手机版| 国产午夜成人AV在线播放| 特级做A爰片久久毛片A片国| 亚洲欧洲精品A片久久99| 亚洲AV久久久噜噜噜久久| 扒开双腿猛进入爽爽在线观看| 影音先锋中文字幕人妻| 久久天天躁狠狠躁夜夜AVAPP | 92久久精品一区二区| 特黄做愛又硬又大A片视频| 精品亚洲国产成人A片在线播放| 免免费国产AAAAA片| 日本一卡二卡三卡四卡无卡免费网站| 日本亚洲精品久久蜜臀| 少妇熟女视频一区二区三区| 欧美精品黄页在线观看视频 | 无码人妻欧美丰满熟妇区毛片| 精品日产一卡二卡四卡| 美女69xxxxx的视频| 色情狠久久AV五月综合五月| 久久久视频2019爱| 最近最新中文字幕大全手机| 高清欧美一区二区三区| 日产在线播放视频在线观看 | 美女被C到爽哭视频网站| 老师的丰满大乳奶| 日韩色情无免费高清在线视频| 国产又黄又猛又粗又爽的A片小说 欧美巨乳大码试穿视频 | 国产又粗又长又大A片激情| 成人片在线观看 免费| 最新 国产 精品 精品 视频| 巜人妻公激情の日本 | 天天看片视频免费观看| 特级做A爰片久久毛片A片国| 久久精品中文騷妇女内射| 久久久国产精品福利免费| 亚洲乱码高清午夜理论电影| 免费视频国产在线观看| 综合无码色情一区二区| 日本边吻奶边挵进去A片无码免| 一女被二男吃奶A片视频| 欧美乱码1卡2卡三卡4卡| 精品国产人妻国语| 国产婷婷亚洲999精品小说| 欧美做爰猛烈大尺度老电影| 亚洲国产精品成人精品A片| 日日摸夜夜添夜夜添高潮免费A片| 老太奶性BBWBBW免费看| 国产AV高清怡春院| 欧美又粗又深又猛又爽A片| 国产又爽又大又黄A片另类软件 | 又大又粗欧美黑人AAAAA片| 欧美又黑又大AAA毛片| 国产五级婬片A片免费| 婷婷激情五月AV在线观看| 久久免费看少妇高潮A片手机版| 日韩亚洲欧美中文高清在线| 亚州久久久久区1区2少妇| 又硬又粗进去好爽A片欧美| 日日鲁鲁鲁夜夜爽爽狠狠| 成人精品一区二区三区A片用毒蛇| 精品久久久久中文字幕日本| 免费一区二区三区无码A片| 精品老牛一卡2卡3卡4卡新版| 少妇人妻邻居做爰无码| 欧美一区二区日韩一区二区| 国产亚洲精品久久77777| 欧美做爰猛烈动高潮视频| 国产特黄又粗又硬A片| 成人免费无码A片免费看软件| 最近2018年中文字幕大全视频| 66亚洲一卡2卡新区成片发布| 欧亚乱熟女一区二区三区在线| 中国欧美日韩一区二区三区| 亚洲欧洲精品A片久久99| 日本一道高清视频1区| 老阿姨儿子一二三区| 国产SUV精品一区二区88L| 国产精品久久久久久日本一道 | 免费观看欧美日韩亚洲| 亚洲精品偷拍AV一区二区| 色国产在线视频一区| 奇米影视7777久久精品人人爽| 极品少妇粉嫩小泬啪啪AV| 国产无遮挡又黄又爽在线视频| 免费一级做a爰片久久毛片潮喷 | 国产乱码一卡二卡3卡4卡网站| 亚洲2017天堂色无码| 最近高清中文在线国语视频| 日欧一片内射VA在线影院| 特级太黄A片免费播放成人片视频| 亚洲熟妇无码AV在线观看网址| 国产美女流白浆的免费视| 欧美巨乳大码试穿视频| 色情五月亚洲中文字幕| 久久免费黄色一级视频| 四lll少妇bbbb搡bbbb| 国产亚洲AV综合一区二区A片 | 熟妇搡bbbb搡bbbb泰国| 少妇被躁爽到高潮| 影音先锋av资源看波波| 免费看的久久久久| 6080YYY午夜理论AA片| 欧美一区二区日韩一区二区| 456亚洲人成影院在线观| 狠狠躁夜夜躁人人爽A片| 重磅发布:人人看AV| 欧美午夜特黄AAAAAA片| 少妇成熟A片无码专区妖精| 亚洲国产成人A片乱码| 国产亚洲精品久久19p| 日本无码免费久久久精品| 在线看片av以及毛片| 中文字幕熟女人妻伦伦在线| 亚婷婷洲AV久久蜜臀无码| 99re这里只有精品97超碰| 欧美高清在线视频一区二区| 无码专区久久综合久综合字幕| 久久福利合集精品视频| 久久久人妻无码A片一区二区三区 白丝高中生被C到爽哭视频 | 高潮失禁喷水流白浆无码| 久久天天婷婷五月俺也去| 亚洲精品久久久一区| 免费无码又爽又黄又刺激网站| 中日韩一卡二卡三卡四卡| 日韩一区二区超清视频| 韩国乱码卡一卡二卡新区网站| 色欲AV久久人妻蜜臀绯色| 免费又黄又爽A片免费看漫画| WBBBB搡BBBB搡BBBB| 国产色情理论在线观看视频| 成人午夜AV亚洲精品无码网站| 偷拍BBB妇女撒尿BBB| 日本少妇BBW丰满做爰图片| 四虎8848a成人亚洲五品 | 午夜久久无码成人免费AV麻豆婷| 久久AV亚洲精品一区无码网| 女人高潮抽搐AAA| 日本又色又爽又黄的A片视频免费| 一级久久久久毛毛A片| 两性午夜刺激爽爽视频| 国产又粗又猛又爽又黄的A片小说| 蜜臀AV999无码精品国产| 少妇BBBB搡BBBB韩国| 女人被狂躁c到高潮喷水一区二区 中国夫妇做人爱视频英文 | 日躁夜躁狠狠躁2001| 国产毛片女人高潮叫声| 午夜夫妻试看120国产| 亚欧色一区W666天堂| 91人妻人人操人人爽人人精品| 1000部丰满熟女富婆视频| 一区二区无码精品AV| ●苍井そらVIP破坏流出无码| 亚洲国产精品成人精品A片| 日韩高清在线观看永久| 国产色情久久久久久久久| 精品日产乱码卡一卡2卡| 精品AV一区二区三区不卡| 国产精品呻吟AV久久高潮| 日日碰狠狠躁久久躁综合网| 天堂AV亚洲AV一二三区| 又硬又粗进去好爽A片免费视频| 玩弄丰满少妇高潮A片91| 日本一道高清视频1区| 欧美S码亚洲码精品M码| 爱我几何无删除原版在哪看| 午夜精品成人一区二区视频| 青青草免费线看v伊人| 搡BBBB搡BBB搡18| 丰满熟妇XXXX性PPX人交| 国产亚洲精品久久久久秋霞不卡| 丰满多毛少妇做爰视频爽爽和R| 胸大美女又黄的网站| 免费无码一区二区三区A片18| 欧美激情综合五月色丁香| 亚洲AV综合色一区二区三区 | 国产亚洲精品久久7777777| 亚洲精品一区二区三区精品| 成年人黄色小视频| 国产亚洲一区二区在线观看| 亚洲精品一区二区成人| 国产成人午夜精品免费视频| 日本私人VPS一夜爽毛| 巜台球室的美丽少妇| 最近2018免费中文字幕1页 | 免费又黄又爽又大又色樱花| 久久人妻无码毛片A片涩天使| 日本乱妇乱熟乱妇乱色A片| 噼里啪啦国语版在线观看 | 日韩欧美视频一区二区在线观看| 黑人狂躁日本妞无码A片| 韩国一区二区视频| 青青青国产在线观看免费 | 久久久精品日韩免费观看| 91在线无码秘 入口在线| 日本少妇做爰免费视频网站| 强被迫伦姧惨叫国产videos| 国产美女被爽到高潮免费A片| 免费一级做a爰片久久毛片潮喷| 欧美产品与亚洲日韩视频| 美女校花被调教出奶水| 欧美亚洲蜜桃成熟| 国产精品人妻无码区刘涛| 丰满人爽人妻A片二区| 777婷婷天堂综合区色吧| 91久久精品国产亚洲| 日本一卡二卡三卡四卡无卡免费网站 | 亚洲AV色情偷拍精品| 在线精品亚洲欧美日韩国产| 国内精品乱码卡一卡2卡| 成年美女黄网站色大免费全看 | 少妇毛又多又黑A片欧美| 亚洲阿v天堂在线2017免费| 国产熟妇精品伦一区二区三区| 99视频这里只有精品国产| 国产午夜亚洲精品午夜鲁丝片| 成人做爰高潮尖叫声免费观看| va天堂va亚洲va影视中文字幕| 国产目拍亚洲精品一区二区三区| 日本特黄无码毛片在线看 | 精品老牛一卡2卡3卡4卡新版| 人妻熟女狠狠涩蜜桃| 欧美一级黄色影院| 爱情岛论坛网亚洲品质自拍 | W无区码一码二码三码| 女邻居夹的太紧太爽了A片| 亚洲欧美一区二区三区久久| 亚洲乱码一卡2卡3卡| 大学生做爰全过程免费的视频 | 亚洲乱熟乱熟女一区二区 | 国产午夜免费视频片夜色| 久久精品国产一区二区三区四区 | 亚洲国产欧美日本视频| 国产福利在线观看片| 亚洲乱码卡一卡二卡新区中国| 97色情在线观看免费高清| 女人被狂躁c到高潮喷水一区二区| 亚洲精品久久久WWW小说| 国产精品久久人妻无码网站一区L| 国产精品 同事 在线 视频| 在线天堂中文最新版www| 熟女人妻久久精品AV天堂| 国产日本精品视频在线观看| 日本一卡二卡三卡四卡无卡免费网站| 东北富婆25分钟对白| 无遮挡BBBBB级A片| 国内精品乱码卡1卡2卡3免费| 水蜜桃一卡2卡3卡4卡| 久久日本片精品AAAAA国产| 成人全黄A片免费看| 真人裸交120秒试看| 俄罗斯6一12呦女精品 | 无码AV国产精品一区二区| 91无码人妻精品国产色情竹菊影视 | 欧美人又长又大又粗无码视频| 国产精品国产对白熟妇| 日本亚洲精品无码专区国产| 国产欧美日韩专区发布| 国产毛片女人高潮叫声| 波多野结衣无码一区二区在线播放 | 色噜噜噜亚洲男人的天堂| 亚洲精品国产综合AV在线观看| 兽交XXXXBBBB视频.| 久久草这里全是精品香蕉频线观| 少妇放荡的呻吟干柴烈火动漫| 无码人妻欧美丰满熟妇区毛片| 国产美女被爽到高潮激情免费A片| 四川少妇BBw搡BBBB槡BBBB蜜臀| 久久日本片精品AAAAA国产| 四川少妇WBBBB搡BBBB嗓| 波多久久亚洲精品AV无码| ●苍井そらVIP破坏流出无码 | 国产女教师一级爽A片色情91 | 黑人配亚洲女人ZOZO| A片扒开双腿进入做爽爽| 久久久无码精品亚洲A片猫咪| 中文字幕亚洲一区| 国产亚洲精品久久久久久鸭绿欲| 亚洲一区二区三区四区五区6区| 兽交XXXXBBBB视频.| 国内精品乱码卡一卡2卡| 亚洲 暴爽 AV人人爽日日碰| 国产传媒18精品A片在线观看| 男女又色又爽又爽视频| 最爽最刺激18禁视频| 国产婷婷亚洲999精品小说| 巨大的奶头被老头玩弄| 日本人妻仑乱少妇A级毛片一 | 亚洲AAAA片色欲aV| 丰满人爽人妻A片二区| 无码人妻一区二区三区A片| 91蜜桃传媒吹潮粉嫩少妇| 国产人妻人伦精品久久无码| 国产美女无遮挡裸体毛片A片软件 国产AV一区二区三区日韩 | 中文字幕理伦午夜福利片| 最新 国产 精品 精品 视频| 被老师粗大jib捣出了白浆视频| 无码又爽又刺激A片涩涩动漫软件| 精品午夜国产福利观看| 亚洲午夜视频在线观看| AV日日碰狠狠躁久久躁| 亚洲AV无码乱码A片无码鱼目珠| 亚洲国产精品成人精品A片| 欧美激情一区二区A片成人| 亚洲精品鲁一鲁一区二区三区| 亚洲精品久久久久久久久AV无码| 无线日本视频精品| 蜜臀AV99无码精品国产专区| 色欲AV蜜臀AV在线观看麻豆| 中文字幕AV影片在线手机播放| 潘金莲一级婬片AAAAAA播放| 免费无套内谢少妇毛片A片软件| 久久精品视频在线看| 少妇被粗大的猛烈进出A片久久久 国产精品AV无码毛片久久 | 婷婷五月色综合人妻| 日本高清一二三不卡区 | WWW.一本色道88久久爱| 国产中文字幕一区| 国产精品视频在线观看| 久久久国产人妻精品| 熟妇的荡欲色综合亚洲图片| J8又粗又硬又大又爽又长A片| A片又大又粗又爽免费视频| 亚洲欧美精品在线| 无码日本大胆XXXX| 久久婷婷五月综合色丁香| 日本一卡二卡三卡四卡手机免费观在线| 99国产精品久久久久久久久久久 | 真人做爰高潮全过程毛片| 97人妻成人免费视频| 日本少妇做爰免费视频网站| 亚洲男人片片在线观看| 日产在线播放视频在线观看| 大桥未久a 一区二区| 男人大JI巴做爰呻吟视频男男 | 久久精品少妇高潮A片免费观| 日本三级人妻一级二级三级| 五月色婷婷中文开心字幕| 日韩一卡2卡三卡4卡精品| 无码欧美激情性做爰免费| 精品 在线 视频 亚洲| 无码视频在线观看| 99久久久无码国产精品免费人妻| 亚洲精品久久国产高清小说| 男女性杂交内射妇女BBWXZ| 国内精品久久久久久网站| 中文有码人妻字幕在线| 刺激成人在线视频观看| 国偷自产视频一区二区久 | 希岛爱理ol丝袜痴汉中出丝裤| 一女三黑人玩4P惨叫A片| 亚洲精品乱码久久久久久日本麻豆 | 国产精品高清视亚洲一区二区 | 精品1区2区3区产品乱码| 少妇放荡的呻吟干柴烈火动漫| 欧美精品久久久久久无码人妻| 免费看毛片的网址| 无套内射GIF舔B吃奶| 日本系列1页亚洲系列| 99久热这里精品免费| 欧美躁天天躁无码中文字| 俄罗斯6一12呦女精品| 日本熟妇人妻另类无码| 精品国产乱码久久久久久软件大全| WWW免费刺激无码又爽又色视频| 亚洲国产精品无码乱码三区红酒| 亚洲国产日韩欧美高清片a| 最好看的2018中文字幕国语| 老人性做爰A片老妇人| 无码人妻一区二区三区蜜桃视频| 一点都不卡的中文视频| 国内揄拍国内精品久久| 成人久久18免费软件| 国产一在线精品一区在线观看| 成人精品国产亚洲AV久久| 高黄暴H日本在线观看| 无套内射视频囯产| 丰满少妇一级A片无码芒果| 99热免费精品店| 一区二区无码精品AV| 国内久久久久久久久久| 99国产精品白浆在线观看免费| 久久中文字幕无码A片不卡古代| 麻花豆传媒剧国产MV动漫在线| 影音先锋a色情av资源| 免费的精品一区二区三区A片| 亲胸摸下面激烈免费网站| 风流少妇BBWBBW69视频| 午夜福利0855免费视频| 天天躁日日躁狠狠躁AV麻豆| 国产又黄又爽胸又大免费视频| 成人做爰免费A片视频二机片| 中文字幕乱码中文乱码777| 中字幕视频在线永久在线| 99精品国产乱码久久久人妻| 性按摩玩人妻HD中文字幕 | 苍井空4D肉蒲团三级无删减版| 2019久久视频国产| 欧美又硬又粗进去好爽A片| 国产小视频免费在线观看| 丰满岳乱妇一区二区三区| 欧美性A片又硬又粗又大暴力| 久久久无码A片观看免费| 精品老牛一卡2卡3卡4卡新版 | 男人吃奶摸下边特黄A片| 国产三级全黄A级视频| 日本又黄又无无遮无码视频| 免费又黄又爽A片免费看| 末路狂花钱免费观看完整普通话| 欧美人与性囗牲恔配的起源| 国产JK白丝喷白浆一区二区| 丰满少妇一级A片无码芒果 | 亚洲卡2卡3卡四卡乱码| 色欲AV久久一区二区三区| 办公室日本肉丝OL在线| 777米奇影院第七色色| 国产乱码免费卡1卡二卡3卡四卡| 亚洲精品久久久中文字幕痴女| 综合精品欧美日韩国产在线| 丰满少妇大力进入AV亚洲| 欧洲无线码免费一区| 精品卡一卡二乱码新区| 精品国产一卡2卡3卡4卡新区| 亚洲精品1卡2卡三卡23卡| 国产黃色A片三級三級三級四川| 久久99青青久久99久久| 综合无码色情一区二区| 日本A片色情AAA片WWW| 国产亚洲精品久久久久久禁果TV| 拔萝卜视频免费看高清| 免费一区二区三区久久| 人妻熟女一二三区夜夜爱| 欧美一区二区日韩一区二区| 无码AV国产精品一区二区| 精品麻豆剧传媒AV国产| 亚洲AV无码专区A片奶水| 青青青爽在线视频观看| 成年美女黄网站色大免费全看| 办公室强奷漂亮少妇视频| WWW日韩AV免费高清看| 无码精品一区二区三区在线A片| 在线观看成人色情视频| 最新国产精品好看的国产精品| 成人性大片免费观看网站YY| 男人大JI巴做爰视频D2| 亚洲熟妇无码乱子AV电影| 国产美女无遮挡裸体毛片A片软件| 国产精品毛片在线完整版SAB| 玩弄少妇的肉体K8经典| 男女激情无遮挡免费视频 | 2022一本久道久久综合狂躁 | 欧美产品与亚洲日韩视频| 国产精品V无码A片在线看| 不小心进了岳坶的身体| 午夜夫妻试看120国产| 97丨九色丨国产人妻熟女| 强制爱(巨肉高H)| 1区2区3区4区产品在线线乱码| 日本毛片爽看免费视频| 韩国精品无码少妇在线观看网站| 人妻互换AV无码打压3p| 五月婷婷激情第四季| 亚洲VA天堂VA欧美片A在线| 国产农村野战胖女人8毛片| chinese山东猛1猛video69| 日日噜噜大屁股熟妇AV张柏芝| 按摩店熟女探花88AV| 亚洲熟妇无码AV在线观看网址| 国产亚洲一区二区在线观看| 日韩视频www色情| 国内精品乱码卡1卡2卡3免费| 国产一卡2卡3卡4卡2021免费观看| 《丰满的女邻居》在线观看| 日韩一区精品视频一区二区| 亚洲国产精品电影在线观看| 蜜臀AV色欲A片精品一区| 成人人妻文学视频红桃| 牲囗与女人性佼播放片| 精品AV中文字幕在线毛片| 精品亚洲卡一卡2卡三卡乱码| 女人高潮被爽到呻吟在线观看| 国产露脸无码A区久久蘑菇| 免费无码又爽又刺激高潮视频日本 | 我学生的妈妈双字ID5| 一本大道伊人AV久久乱码| 特级淫片aaaa毛片aa视频| 成人A片一区二区三区在线观看| 精品国产成人国产在线观看 | 色老头AV亚洲一区二区男男| 日本一卡二卡三卡四卡无卡在线观看免费软件| 精品亚洲一区二区在线播放| 亚洲AV综合AV一区二区综合| 影音先锋av色噜噜影院| 成人网站免费大全日韩国产| 熟女人妻-蜜臀AV-首页| 真人做爰高潮全过程毛片| 欧美肥老太WBWBWBB| 亚洲精品一区久久久久久| 人妻无码AV中文系列免费| 久久免费看少妇高潮A片特爽| 男人在天堂a视频| 国产人妻精品午夜福利免费不卡| 熟女肥臀白浆大屁股一区二区 | 精品国产成人AV在线看| 国产亚洲精品久久久久久入口| 国产人伦人妻精品一区| 日本熟妇浓密毛毛多A片| 最近2019中文字幕一页二页| 亚洲午夜精品A片久久不卡蜜桃| 超碰在现线久2019| 久久精品国产视频在热| 欧美黑人狂躁日本妞免费视频| 欧美日韩一区在线观看| 国产激情无码激情A片软件| 777午夜福利理伦电影网| 亚洲色婷婷久久精品AV蜜桃久久 | 国产成人精品视频VA片| 久久亚洲A片COM人成A| 99久久久无码国产精品免费人妻 | 乱码一二三四视频不卡| 久久日本片精品AAAAA国产| 丰满的子3中文电影| 亚洲天堂2017手机在线| 麻花豆传媒剧国产免费MV在线 | 久久人人爽人人人澡A片| 国产精品亚洲二线在线播放| 丰满熟妇XXXX性PPX人交| 成人婷婷网色偷偷亚洲男人的天堂| 国产又大又粗又硬的A片| 久久AV无码乱码A片无码蜜桃| 欧美特级特黄AAAAA片| 国产爱豆剧果冻传媒在线| 先锋影音avt天堂影院| 亚洲AV成人噜噜无码网站A片| 性XXXXX搡XXXXX搡景甜| 成人亚洲A片V一区二区中出片| 欧美日韩中文国产一区| 国产午夜亚洲精品午夜鲁丝片| 性夜黄A片爽爽免费视频| 国产V日产∨综合V精品视频麻豆| 韩国一区二区视频| 海角社区最新在线播放| 久久草这里全是精品香蕉频线观| 久9青青cao精品视频在线| 国产亚洲日本精品无码电影| 99在线精品国自产拍不卡| 国产又大又粗又猛又爽日本| 国产午夜精品一区二区三区四区| 乱码一二三四视频不卡| 青青草国产免费一区二区| 日本VS中国VS亚洲看无码A| 国产成人午夜精品5599| 少妇熟女视频一区二区三区| 久久精品国产男包| 免免费国产AAAAA片| 国产欧洲一卡2卡3卡4卡| 苍井空激烈的120| 免费无码又爽又刺激高潮视频日本| 在办公室少妇做爰| 最新 国产 精品 精品 视频| 国产又粗又黄又爽的A片精华液 | 国产97精品无码A片在线看密| 国产乱妇乱子在线视频| 兽交XXXXBBBB视频.| 欧美又黄又大又爽A片| 亚洲精品一区二区三区无码A片| 精品99卡1卡2卡3乱码| 色偷偷资源亚洲在线| 97久久精品人人爽人人爽蜜臀| 欧美又长又大又深又爽A片特黄 | 熟女无套内射线观56| 日本一卡二卡三卡四卡无卡免费网站| 国产亚洲精品久久久久久禁果TV| 亚洲精品无码成人A片在线软件 | 在线精品亚洲欧美日韩国产| 亚洲精品久久久一二三区| 丰满少妇黑森林A片| 亚洲中文在线无码永久色情| 亚洲精品久久久一区| 神马影院夜伦鲁鲁片| 囯产精品久久久久久久久久三级| 天天摸夜夜摸摸到高潮| 亚洲精品无码成人A片在线软件 | 一色桃子中文字幕人妻熟女作品| 国产WW久久久久久久久久| 国产亚洲色婷婷久久99精品男同 | 日本毛片爽看免费视频| 国产人A片在线乱码视频| 手机国产视频福利| 日本少妇做爰片视频R| 久久99国产综合精品免费| 欧美激情A片一区二三区| 国产熟人AV一二三区| 伊人大香 蕉75在线观看| 日本久久精品视频| 日韩MV欧美MV中文无码| 狠狠躁日日躁夜夜躁A片小说| yy6080午夜色情理伦片在线| 亚洲精品久久久久久久久AV无码| 国产精品久久久久久日本一道| 国产美女一级做a爱视频| 精品一卡2卡三卡4卡乱码免费| 无码精品一区二区三区潘金莲| 一级a爱视频免费久久| caoporn成人免费视频| 国产精品亚洲视频在线观看| 久久久久久久久66精品片| 欧洲熟妇大荫蒂高潮A片视频| 中文字幕亚洲码在线| 99在线在线视频观看| 国产亚洲精品久久久一区| 国产午夜视频在线观看| 国产一卡2卡3卡4卡孕妇网站| 亚洲精品成AV人片天堂无码| 六月丁香 五月婷婷小说| 青草草97久热精品视频| 亚洲gogo人体大胆西西安徽| 国产女女精品视频久热视频| 久久草香蕉频线观| 欧美三级黄色大片| 在线最新av免费费观看| 中文精品一区二区三区四区| 久久日本片精品AAAAA国产 | 日韩精品免费在线观看| 五月综合激情婷婷六月| av小四郎收藏家网站| 成人性大片免费观看网站YY| 国产精品禁18久久久夂久| 国产午夜精品一区二区三区四区| 一区二区三区精品道| 趴玻璃上做给别人看宝贝| 奶涨边摸边做爰69式视频| 白嫩哺乳期人妻老师| 亚洲精品嫩草AV在线观看| 无套内谢少妇毛片A片免费视频| 亚洲精品爆乳一区二区H| 国产精品久久国产三级国电话系列| 国产传媒免费看A片| 99E久热只有精品8在线直播| 麻豆果冻传媒在线观看| 精品1区2区3区产品乱码| 日韩MV欧美MV中文无码| 国产欧美在线播放| 被男人添B超爽视频免费| 中文字幕AV亚洲精品影视| 最新版天堂网WWW| 一区二区三区日韩免费播放| 久久久久久久国产精品视频| 51无人区码一码二码三码区别| 欧美激情无码视频一二三| 女人高潮抽搐AAA| 边啃奶头边躁狠狠躁A片动漫| 久久AV无码乱码A片无码软件 | 日本乱码卡一卡新区入口| 在线免费黄色鲁喷少妇诱惑| 无码人妻视频又大又粗欧美| 骚虎视频在线观看| 亚欧日韩毛片在线看免费网站| 又大又粗成人A片免费看| 久久高清免费视频| 国产传媒18精品A片在线观看| 色情五月亚洲中文字幕| 国产熟妇搡BBBB搡BB七区| 国产精品伦子伦免费高清软件| 老头老太做爰XXX| 久久无码精品一区二区三区第1集| 成人无码A片一区二区三区免| 中文字幕日产A片在线看| 无码激情做A爰片毛片A片蜜桃| 黄se网站是多少2013| 丰满多毛少妇做爰视频爽爽和R| 国产精品久久久久久影院| 国产精品久久久久久搜索 | 和黑人高潮了10次A片| 人人妻人人爽人人添夜夜| 亚州精品久久久久久久久| 爱如潮水免费5观看视频韩国| 青青草a免费线观a| 美女翘臀强进入系列在线观看 | jlzzzjizzzjlzzz亚洲| 中文字幕日产A片在线看| 天堂中文最新版www官网| 国产亚洲精品久久久久久国| 国产AV国片精品一区二区| 女心理师电视剧在线观看完整版| 日韩卡一卡二卡乱码新区| 亚洲精品日韩一区二区电影| 一区二区三区日韩免费播放| 国产精品亚洲精品久久国语| 色婷婷亚洲婷婷五月| 乱码一二三四视频不卡| 亚洲一卡2卡3卡4卡 高清| 男人大JI巴做爰呻吟视频男男| 天天爽亚洲中文字幕| 亚洲国产卡1卡2卡34卡| 日本少妇BBW丰满做爰图片| 日韩免费A片奶头| 精品卡一卡二新区入口| 亚洲欧美日本久久综合网站| 国产黃色A片三級三級三級四川| 亚洲最大的色情网COM| 国产成人在线播放| 久久精品视频在线看| 插的痛的视频一卡二卡三卡| 与富婆激情拍拍视频在线观看| 无套内谢少妇毛片A片免费视频| 男人把我添到了高潮A片| 成人免费午夜在线观看| 亚洲AV成人天堂影院| 国产精品毛片AV999999| 精品国产成人国产在线观看| 免费无码一区二区三区A片视频| 久久精品视频在线直播6| 国内久久久久久久久久| 欧美人做人爱A全程免费| 亚洲男人97色综合久久久| 国产露脸无码A区久久蘑菇| 无码AV免费精品一区二区三区| 无套内谢少妇毛片A片小说| 萌白酱17分钟视频| 亚精区在二线三线区别第一基 | 亚洲午夜精品毛片成人播放器| 在线青青视频免费观看| 一区二区视频在线观看高清视频在线 | 又大又粗的欧美激情A片| 国产精品久久久久久搜索| 日本乱妇乱熟乱妇乱色A片| 四个熟妇搡BBBB搡BBBB| 亚洲精品久久一区二区三区四区| 亚洲精品无码高潮喷水A片在线| www国产亚洲精品久久网站| 亚洲AV久久无码精品国产网站| 真人性做爰A片免费| 免费看成人AA片无码视频羞羞网| 久草原精品资源视频| 国模冰冰大胆瓣开下部| 成人无码T髙潮喷水A片小说| 国产熟女内射OOOO| 国产高清色情在线观看APP | 足浴口爆吞精【20p】| 97伦伦午夜电影理伦片| 很黄又污又色情又爽又猛| 搡BBBB搡BBBB搡BBBB| 精品国产一卡2卡3卡4卡新区| 色婷婷亚洲婷婷五月| 久久婷婷五月综合色情 | 久久精品免费人成人A片| 欧美又粗又黄又硬的A片| 精品日本亚洲一区二区三区| 日产高清卡1卡2卡三卡在线| 伊人亚洲AV久久无码精品| 中文字幕丰满孑伦无码专区| 老司机无码精品A| 玫久热这里只有精品2| 国产成a人亚洲精品无码樱花| 免费AA片少妇人AA片直播| bt天堂在线WWW中文| 亚洲精品1卡2卡三卡4卡乱码| 男人强撕开奶罩揉捏我奶头视频| 亚洲欧美中文字幕高清在线| 久久人人做人人妻人人玩精品AV| 国产乱码免费卡1卡二卡3卡四卡| 五月婷婷六月激情| 欧美激情A片一区二三区| 久久亚洲精品AV成人无码| 日日做A爰片久久毛片A片英语 | 国产精品高清视亚洲一区二区| 91精品国产高清久久久久久| 青青草免费线看v伊人| 55夜色66成年视频观看免费| 在线视频一区二区三区在线播放| 亚洲国产传媒色情AV| 精品AV亚洲一区二区| 亚洲精品无码成人A片在| 国产亚洲精品第一区香蕉| 亚洲AV久久无码精品热九九| 国产69精品久久久久久人妻精品| 国产免费无码又爽又刺激A片| 国产熟妇无码一区二| 国产高清色情在线观看APP | 色欲AV性色av浪潮AV壹牛网| bt天堂在线WWW中文| 欧美激情无码视频一二三| 丰满多毛少妇做爰视频| 直接看的成人无码视频网站| 妇女敕BBB搡BBBBBB搡| 1000部毛片A片免费观看| 51久章草在线视频| 強奷漂亮少妇高潮A片P夜夜嗨| 国产美女无遮挡裸体毛片A片 | 激情深入内射在线播放| 中无码人妻丰满熟妇啪啪18禁| 国产精品人妻熟女a8198v久| 又大又粗又爽的少妇免费视频| 综合无码色情一区二区| 98久久无码一区人妻A片蜜| 国产一卡2卡3卡4卡2021免费观看| 最近新免费韩国视频在线观看| 未满小14洗澡无码视频网站 | 秋霞免费鲁丝片无码| 亚洲中文超碰中文字幕| 国产亚洲精品字幕在线观看| 大学生做爰全过程免费的视频| 蜜臀AV色欲无码A片一区| 四川少妇BBBB槡BBBB槡| 欧美 亚洲 有码中文字幕| 中文字幕 在线 欧美 日韩 制服 | 色偷偷噜噜噜亚洲男人| 久久亚洲A片COM人成A| 少妇呻吟白浆高潮啪啪69| 欧美丰满大乳无码少妇| 久久2017国产视频| 亚洲第色情一区二区| 性妇WBBBB搡BBBB嗓小说| 精品成人无码A片观看香草视频| 肉到痉挛中出痴汉在线播放| Japanese熟妇AV一区二区| 久久精品AV一区二区无码| 最近更新中文字幕在线2018二| 91麻精品国产91久久久久| 日本三级吃奶头添泬播放| 男人的天堂亚洲一线AV在线观看 | 中文字幕在线观看亚洲日韩| 最新亚洲国产手机在线| 国产一卡2卡3卡4卡孕妇网站| 国产精品久久久久久无码五月蜜臂 | 伊人亚洲AV久久无码精品 | 亚欧人妻精品AV熟女人妻| 国产SUV精品一区二区88L| 日韩精品免费在线观看| 国产在线视频精品视频| 国产无遮挡A片又黄又爽女同 | 99精品国产免费久久久久久下载| 四川BBB桑BBB桑BBB| 欧美日韩一级黄色片| 精品国产成人AV在线看| 日本妇人成熟免费中文字幕| 艳妇臀荡乳欲伦交换AV1| 国产农村妇女毛片精品久久久久| 办公室强奷漂亮少妇视频| 国产成人午夜极速观看| 精品熟女少妇AV久久免费软件| chinese山东猛1猛video69| 欧美黑大粗无码免费视频| 办公室强奷漂亮少妇视频| 扒开女人两边毛耸耸| 国产成人精品久久一区二区三区| 桃谷绘里香初尝黑人巨炮网址| 又大又粗又爽的少妇免费视频| 精品 在线 视频 亚洲| 加勒比AV一本大道香蕉大在线 | 亚洲乱码在线卡一卡二卡新区 | 国产精品女A片爽爽免费按摩| 国产一性一交一伦一A片小说| 国产亲子伦XXXXX熟妇| 国内精品久久久久久网站| 老妇槡BBBB槡BBBB槡| 无码免费人妻A片AAA毛片| 中日韩一卡二卡三卡四卡| 日韩中文亚洲欧美视频二| 永久免费看A片无码精品| 91丝袜白浆高潮潮喷在线观看| 免费看成人AA片无码视频羞羞网 | 少妇伦子伦精品无码| 强行糟蹋人妻HD中文字幕| 国产一卡 二卡三卡四卡无卡乱码视频 | 欧美成人看片一区二区三区尤物| 午夜久久无码成人免费AV麻豆婷 | 日韩一区精品视频一区二区| 中文字字幕在线中文乱码2019| 国产男女猛烈无遮挡A片游戏| A片人澡C片人人妻| 久久久久久久国产免费看| 国产精品女A片爽爽免费按摩| 久久青青草视频在线观| 久久精品出轨人妻国产| 亚洲成年网站在线观看| 亚洲AV成人片色在线观看高潮| 国产全是老熟女太爽了| 人妻无码AV中文系列免费| 欧洲5卡6卡7卡老狼在线| 白天躁晚上躁天天躁COM乡| 国产人妻人伦精品1国产| WWW日韩AV免费高清看| 国产精品人妻一区夜夜爱| 国产人妻人伦精品9| 国产又黄又爽又刺激的免费网址| 少妇久久久久久被弄高潮| 国产美女无遮挡裸体毛片A片软件 国产AV一区二区三区日韩 | 国产美女黄性色A片| 欧美日韩精品一区二区三区高清视频| 国产开女娃苞A片在线播放| 一区二区三区A片无码视频不卡 | 在线免费黄色鲁喷少妇诱惑| 国产成人精品免费久久久久| 日日躁夜夜躁狠狠久久AV| 日韩精品卡1卡二卡3卡四卡| 欧美又大又色又爽AAAA片| 午夜福到在线2019| 欧美69久成人做爰视频| 91久久国语露脸精品国产高跟| 免费无码一区二区三区A片18| 亚洲不卡一卡2卡三卡4卡5卡 | 97国产精华最好的产品久久久| 国产欧美一区二区三区久久| 偷录到真实的叫床声视频| 亚洲中文字幕无码一久久区| 欧美乱码1卡2卡三卡4卡| 女人高潮喷潮免费毛片| 日韩免费视频一区| 五十路丰满老熟女人妻图片| 亚洲暴爽AV天天爽日日碰| 国产精品综合亚洲AV久久久小说| 成人网站AA片男女大战| 激情五月色综合国产精品| 亚洲一区AV在线观看无码漫画| 欧美日韩一区二区三区四区| 国产亚洲精品久久19p| 少妇水多A片太爽了| 亚欧色一区W666天堂| 欧美人与动牲交ZOOZ特| 日本久久久WWW成人免费毛片丨| 青青视频精品观看视频| 色偷偷的xxxx8888| 亚洲AV久久久噜噜噜噜| 五月综合激情婷婷六月| 69无人区码一码二码三码| 无套内谢少妇毛片A片免费视频| A一特级欧美毛片香蕉| 国内精品久久久久久网站| 五十路近親相姦中出し親子| 日韩精品在线观看免费| 国产传媒免费看A片| 高潮迭起AV乳颜射后入| 又黄又刺激的网站| 最近更新中文字幕免费完整版| 免费含羞草AV片成人| 国产亚洲精品久久久一区| 久久视频在线观看精品| 国产高清无码在线播放最新| 日本五十路有码中文中出| 少妇高清精品毛片在线视频| 久久精品国产男包| 19不插片免费视频| 花蝴蝶免费高清视频中国| 精品亚洲国产成人A片在线播放| 日韩视频www色情| caoporn成人免费视频| 午夜色情影院色a国产 | 久久免费看少妇高潮A片小说| 国产麻豆果冻传媒视频观看| 国产亚洲精品品视频在线| 久久久久久国产视频| 天堂最新版www官网| 久久亚洲A片COM人成A| 艳妇臀荡乳欲伦交换AV1 | 精品卡一卡二乱码新区| 巨大乳首に揉んで乳搾り| 四虎影库永久地址发布| 亚洲A片成人无码久久精品| 孰妇XXXXXX的性生话| 日本熟妇浓密毛毛多A片| 精品无人区麻豆乱码1区2区新区 | 韩国乱码卡一卡二卡新区网站| 久久久日韩精品一区二区| 亚洲AV无码乱码A片无码鱼目珠| 精品日韩二区三区精品视频| 精品亚洲国产成人A片APP| 国产人妻人伦精品熟女A片| 中文字幕欧美一区| 欧美又黄又大又爽A片| 欧美日韩中文国产一区| 最爽最刺激18禁视频| 久久青青无码AV亚洲黑人| 日韩成人毛片高清视频免费看| 国产熟女内射OOOO| 午夜人妻无码一区二区三区蜜桃视频 | A级无遮挡超级高清-在线观看 | 2017亚洲天堂最新地址| 未满小14洗澡无码视频网站| 欧美一区二区高清| 一区二区乱子伦在线播放| 免费无码又爽又刺激A片软| 日本熟妇人妻另类无码| 亚洲AV永久无码精品国产精| 国产精品亚洲精品久久久久| 无人一码二码三码4码免费| 欧美日韩亚洲一区二区三区在线观看| jk制服两腿打开露内衣h文| 丰满岳乱妇一区二区三区| 日本A级做爰午夜免费视频| chinese山东猛1猛video69 | 永久黄网站色视频免费| 精品无人区麻豆乱码1区2区新区| 人人爽久久久噜噜噜丁香AV| 1区2区3区4区产品在线线乱码 | 四平青年之喋血曼谷免费观看完整| AAA级无码肉欲免费看| 久久精品国产免费中文| 日本A片特黄久久免费观看| 国产69精品久久久久人妻刘玥| A级A片A少妇高潮| 欧美日韩中文国产一区| 国产清纯粉嫩初高生色情软件| 国产18在线观看17c| 久久精品视频在线看| 91在线视频免费看| 人妻少妇被粗大爽9797PW | 国产五级婬片A片免费| 夜夜躁天天躁很躁MBA| 成人乱码一区二区三区A片| 日本妇人一成熟A片高潮| 中文字幕一区二区视频| 免费精品美女久久久久久久久| 无码毛片A片-区二区三区| 午夜国产精品免费观看| 午夜成人小视频在线观看| 99国产亚洲精品久久久久久| 午夜精品白在线观看| 苍井空a v免费视频| 亚婷婷洲AV久久蜜臀无码 | WWW国产亚洲精品久久| 免费视频国产在线观看网站| 亚洲精品久久久WWW小说| 欧美精品狠狠色丁香婷婷| 任你搞视频这里只有精品| 日产精品卡1卡2卡三卡在线| 国产精品久久久久久福利| 高潮无遮挡成人A片| 亚洲第一免费播放区| 国产福利在线观看片| 教室停电H嗯啊好硬好湿攻守| 亚洲一卡二卡三卡四卡无卡网站 | 伦理电影v男人天堂| 亚洲AAAA片色欲aV| 男女做爰无遮挡性视频| 亚洲AV国产精品无码精| 日韩人妻色情欲网站德国熟妇AV | 国产成人A片免费观看| 九九精品国产亚洲A片无码| 国产美女流白浆的免费视| 2022一本久道久久综合狂躁 | 国产精品婷婷五月久久久久| 97人妻成人免费视频| 精品日韩卡1二2卡3卡4卡乱码| 浪荡女天天不停挨CAO日常视频| 久久精品国产亚洲AV影院| 亚洲精品AV无码喷奶水糖心| 中文字幕亚洲码 在线观看| 无码区国产区在线播放| 超级吹潮高手喷40秒视频| 欧美激情无码视频一二三| 亚洲一区免费观看| WWW国产成人免费观看视频| 中文字幕精品无码一区二区 | 97成人碰碰在线人妻少妇| 日韩一卡2卡3卡4卡乱码网站导航| 丰满女邻居的嫩苞张开视频| 久久受www免费人成_看片中文| 欧美人与性囗牲恔配的起源 | 午夜精品国产精品大乳美女| 亚洲老熟女AV一区二区在线播放| 日韩欧美一区二区三区免费观看| 夜夜穞天天穞狠狠穞AV美女按摩| 无码欧美精品一区二区蜜桃色欲 | 久久AV无码乱码A片无码软件| 国产精品久久久久9999爆乳 | 日韩少妇内射免费播放| 亚洲国产卡1卡2卡34卡| 天堂网WWW最新版| 曰本一道本久久88不卡| 国产欧美一区二区三区免费视频| 欧美整片sss第一页视频| 无码免费婬AV片在线观看cos | 少妇呻吟白浆高潮啪啪69| 婷婷开心情五月色在线| 国产乱码免费卡1卡二卡3| 久艾草在线精品视频在线观看| 亚欧色一区W666天堂| 国产精品亚洲综合一区二区三区| 日本边吻奶边挵进去A片无码免| 国产一级黄片免费观看| 亚洲精品无码高潮喷水A片在线| 国产精品人妻出轨AV大片| 日韩免费一区二区三区在线 | 成人国产精品日本在线| 国内精品乱码卡1卡2卡3免费| 91精品国产高清久久久久久 | 无码又爽又刺激A片涩涩动漫| 最好看免费中文字幕2018| 精品国产91乱码一区二区三区| 国产精品久久久久9999小说| 91系列在线观看免费| 最新 国产 精品 精品 视频| 国产白嫩护士在线播放| 桃谷绘里香初尝黑人巨炮网址| 国产精品成人无码A片免费网址| 久久无码潮喷A片无码高潮动漫| 国产一性一交一伦一A片视频| 国产看真人毛片爱做A片| 正在播放夫の前で痴汉に绝顶| 五月丁香五月伦理| 日韩一区二区超清视频| WWW国产亚洲精品| 欧美精品无码久久久潘金莲| 越南女子杂交内射BBWBBW| 久久草香蕉频线观| 噼里啪啦的动漫免费看| 国产69熟妇视频天美| 老妇槡BBBB槡BBBB槡| 精品熟女少妇AV久久免费软件| 激情偷乱人成视频在线观看| 欧美精品无码久久久潘金莲| 国产高清乱理伦片中文小说| 国产亚洲精品AAAA片APP| 久久国产免费观看精品A片| 高潮娇喘抽搐A片无码黄| 欧美成人无码视频午夜福利| 久久草这在线观看免费| 日产免费一二三四区禁止转发传播| 2018日韩朝吹一本到| 欧美又爽又大又黄A片| 乡下妇乱子伦小说| 少妇被多人C夜夜爽爽| 乱理片 最新乱理片2018| 国产午夜成人AV在线播放| 国产欧美日韩视频免费| 国产精品看高国产精品不卡| 69久久无码一区人妻A片| 国产亚洲精品AAAA片APP| 天堂在线www最新版资源| 亚洲精品国产成人无码区A片| 国产亚洲精品AAAA片APP| 99re这里只有精品97超碰| 无人一码二码三码4码免费| 蜜臀AV色欲A片无码一区二区| 真实国产熟睡乱子伦对白无套| 人妻无码AV系列久久电影| 色情免费网址直接观看| 午夜无码熟熟妇丰满人妻| 亚洲无吗精品AV九九久久| 2019年92午夜视频福利| 九色终合九色综合88| 囯产精品一区二区三区线| 国产精品人妻无码久久久豆腐| 九九99亚洲精品久久久久| 天堂tv亚洲tv日本tv不卡| 久久久无码精品亚洲A片0000| 精品国产久线观看视频| 国产亚洲精品久久AV| 日本三级人妻一级二级三级| 加勒比AV一本大道香蕉大在线| 性按摩玩人妻HD中文字幕| 最近中文字幕在线中文视频| 国产精品伦子伦免费高清软件| 国产人妻spa按摩在线91| 中文字幕亚洲码在线| 蜜月a 免费一区二区三区| 高清欧美一区二区三区| 久久精品视频在线看4| 无码人妻视频又大又粗欧美| 五月六月丁香婷婷激情| AAA级无码肉欲免费看| 亲胸摸下面激烈免费网站| 国产AV无码熟妇人妻麻豆| 少妇久久久久久被弄高潮| 日韩欧美视频一区二区| 爆乳3把你榨干哦OVA在线观看| 偷录到真实的叫床声视频| 北京50岁退休熟女嗷嗷叫| 无码人妻丰满熟妇啪啪欧美| 亚洲狼人伊人中文字幕| 亚洲综合AV色婷婷五月蜜臀 | 美女翘臀强进入系列在线观看| 少妇被躁爽到高潮无码A片小说| 成人污污视频在线观看| 精品成品国色天香卡一卡MBA | 成人MV射精无打码视频| 性色AV久久一区二区| 国产福利一区二区三区在线视频| 在线观看日韩一区| 丁香五月久久婷婷久久| 麻花豆剧国产MV在视频播出| 伸进护士的小内裤疯狂揉摸| 久久亚洲精品无码A片大香大香| 97久久精品人人爽人人爽蜜臀| 国产在线看片免费视频| 日本乱理伦片在线观看胸大| 亚洲性无码A片在线观看尖叫| 国产97精品久久久天天A片| 日本乱码卡一卡新区入口| 亚洲中文超碰中文字幕| 韩国大尺度理伦片A片| 欧美日韩一区二区综合在线视频 | 亚洲AV久久久噜噜噜熟女软件| 日韩亚洲欧美中文在线| 亚洲区色情区激情区小说纯熟调抖 | 终极蜘蛛侠动画片全集| 色欲人妻AV久久无码精品| 亚洲男人电影天堂无码| 亚洲精品乱码久久久久久日本麻豆 | 欧美经典影片视频| 啦啦啦 中国 日本 免费观看 | 亚洲欧美色图小说| 日韩欧美一区二区三区免费观看| 四川少妇bbw搡bbbb槡bbbb| 国产一级特黄a大片99| 宅男午夜大片又黄又爽大片| 美熟丰满老妇女bbw| 国产亚洲精品一区二三区| 国产亚洲欧美在线观看三区| 免费区大尺码体验区| 日本乱子伦一区二区三区| 色欲AV亚洲A片永久无码精品| 精品国产成人AV在线看| 国产午夜精品一区二区三区嫩草| 四川少妇BBBB槡BBBB槡| 爱如潮水免费视频播放| 四lll少妇bbbb搡bbbb| 亚洲成年网站在线观看| 中文字幕专区高清在线观看| 91拍真实国产伦偷精品| 91久久国语露脸精品国产高跟| 在线视频一区二区三区四区| 丁香花在线电影小说观看| 琪琪电影网www888dvdc| 无码免费视频AAAAAA片草莓 | 无遮挡BBBBB级A片| 唐人呦一呦xxxx视频| 亚洲综合AV色婷婷五月蜜臀| 成人午夜视频一区二区国语| 777午夜福利理论电影网| 熟妇人妻中文字幕无码老熟妇| 女乱高潮久久久久久爽爽电影| 少妇水又多又黑又长A片动漫| 色国产在线视频一区| 男人天堂网2018最新地址| 亚洲精品久久久久久中文| 亚洲欧洲精品A片久久99| 国产成年无码V片在线| 日本久久精品视频| 欧美群妇大交乱免费视频| 搡老熟女老女人一区二区| 肉到痉挛中出痴汉在线播放| 丁香六月深婷婷激情五月| 强壮的公么征服我 在线看| 少妇被又大又粗又爽毛片欧美一| 亚洲精品一区二区三区精品| 日本无码免费久久久精品| 丰满老熟妇BBBBB搡BBB| 69精品国产久热在线观看| 成人午夜精品网站在线观看| 黄色一级片免费在线观看| 日本高清2018字幕| 午夜精品视频在线无码| 成人无码髙潮喷水A片| 国产极品白丝玉足喷白浆高潮视频| 亚洲欧洲精品A片久久99| 99SE久久爱五月天婷婷| 九色终合九色综合88| poronovideos人初重口| 日本高清一二三不卡区| 日韩高清在线观看永久| 国产熟妇精品伦一区二区三区| 大尺度激情做爰A片纯真时代 | 亚婷婷洲AV久久蜜臀无码| 久久久GOGO无码啪啪艺术| 最近2018年中文字幕免费图片| 小伙无套内射老女人| 精国产品一区二区三区A片| 国产精品久久久久久影院| 韩国免费理论片A级奶大| 狼狼躁日日躁夜夜躁A片| 国产一区在线观看免费| 久久亚洲精品中文字幕无男同| 92午夜福利视频在线看| 五月婷婷之综合缴情| 少妇被粗大的猛烈进出A片久久久| 日本无码免费久久久精品| 亚洲一卡2卡3卡4卡精| 国产69精品久久久久人妻刘玥| 久久视频这只精品99re6| 亚洲精品国产成人无码区A片| 又污又黄又无遮挡的网站国产| 久久亚洲精品高潮综合色A片| 色情狠久久AV五月综合五月| 和黑人高潮了10次A片| 极品JK小仙女自慰喷水牛牛影视| 欧亚成人A片一区二区| 黑人强伦姧人妻日韩那庞大的| 色婷婷色综合缴情网站| 亚洲AV久久久噜噜噜噜| 国产成人一区二区三中文| 99久久精品费精品国产| 在线天堂中文最新版www下载| 亚洲婷婷国产精品电影人久久| 精品一卡二卡三卡四卡视频区| 丰满人妻熟女色情A片| 69无人区码一码二码三码区别| 男女性杂交内射妇女BBWXZ| 日韩欧美一区二区三区在线| 欧美jizzhd精品欧美满| 国产18在线观看17c| 国产亲子伦XXXXX熟妇| 羽月希被黑人吃奶dasd585| 老阿姨儿子一二三区| 老富婆全程露脸在线观看| 久草热久草在线视频| 91久久国语露脸精品国产高跟| 午夜激情在线观看| 又大又粗成人A片免费看| 免费毛片a在线观看67194| 偷偷鲁手机在线播放AV| 老师我好爽再深一点动态图 | 国产午夜视频在线观看| 亚洲精品国产成人无码区A片| 国产成人无码精品久久久影院| 西西4444www无码大胆| 国产精品久久久久久影院| 日韩一级特黄毛片在线看| 国产AV亚洲精品久久久久软件 | 国产农村野战胖女人8毛片| 欧美人妻精品久久久久久| 国产午夜毛片成人网站| 国产看真人毛片爱做A片| 成年人黄色小视频| 正在播放夫の前で痴汉に绝顶| 亚洲婷婷六月的婷婷| 中文字幕日产A片在线看| 欧美S码亚洲码精品M码| 在办公室少妇做爰| 国产婷婷午夜精品无码A片| 4455永久在线观免费看片| 噜噜噜AV在线观看| 亚洲中文在线无码永久色情| 婷婷伊人綜合亞洲綜合網| 色欲av亚洲情无码av蜜桃| 无码人妻熟妇AV又粗又大A片| 亚洲一区精品在线| 国产农村妇女毛片精品久久久久| 精品AV中文字幕在线毛片| ●苍井そらVIP破坏流出无码| 最新无码国产在线视频xyz| 日韩色情无码一本二本三本| 99久久精品费精品国产| 免费又黄又爽又大又色樱花| 国产AV亚洲精品久久久久软件| 日本无码欧美激情在线视频| 免费A片全黄少妇7777| 人妻无码AV中文系列免费| 亚洲中文无码AV在线观看| 少妇夹得好紧太爽了A片| 国产成人无码免费看视频软件| 亚洲AAAA片色欲aV| 国产亚洲精品久久久久久老妇小说| 特级太黄A片免费播放成人片视频| 2018日韩朝吹一本到| 国产精品亚洲二线在线播放| 欧美国产日产一区二区| 亚洲国产欧美日本视频| 欧洲精品不卡1卡2卡三卡四卡| 91豆麻精品91久久久久久| 免费一级做a爰片久久毛片潮喷| 日本一卡二卡三卡四卡免IOS| 国产精品顶级A片无码久久久| 天天躁日日躁狼狼超碰97| 亚洲欧美中文字幕高清在线| 免费看少妇高潮A片黄| 无码日本精品一区二观看| 日本MV在线观看永久免费| 亚洲A片无码一区二区三区公司| 丰满少妇一级A片无码芒果| 无码人妻熟妇AV又粗又大A片| 亚洲精品无码成人A片在线古代| 午夜精品久久久久久久爽| 成人国产在线不卡视频| 亚洲第色情一区二区| 国产色情A久久无码影| 男插女一起爽的免费樱花小视频| 亚洲午夜精品A片久久软件| 国产精品久久久久久亚洲影视| 女人天堂高清在线播放| 懂色Av一区二区三区四区在线播放 | 四川少妇BBw搡BBBB槡BBBB蜜臀| 熟女少妇人妻中文字幕| 久久免费视频精品在线| 国产亚洲精品久久久久久国| 久久免费视频精品在线| 99精品丰满人妻无码A片| 亚洲人成人网毛片在线播放| 亚洲欧美日韩一区二区| 国产一卡2卡三卡4卡免费网站| 国产微拍一区二区三区四区 | 精品日产一卡2卡三卡4卡在线| 成人MV射精无打码视频| 亚洲精品久久无码AV片亚洲| 国产又爽又猛又粗的视频A片| 嫩草国产露脸精品国产软件| 久久中文字幕无码A片不卡古代| 风间由美人妻无码AV| 国产乱子影视频上线免费观看| 免费不卡视频一卡二卡| 亚洲国产成人A片乱码| 亚洲日本久久久午夜精品| 玩弄少妇的肉体K8经典| 午夜妇女AAAA区片| 97人妻成人免费视频| 久久久精品免费视频| 熟妇乱子作爱视频大陆| 少妇我被躁爽到高潮A片| 熟妇无码乱子成人精品| 国产高清无码在线播放最新| 护士张开腿被奷日出白浆| 终极蜘蛛侠动画片全集| 亚洲AV成人男人的天堂网| 亚洲精品久久99蜜芽尤物TV| 色欲AV天天AV亚洲一区| 无码国产精品成人午夜视频| 久久精品国产男包| 又污又黄又无遮挡的网站国产| 三上悠亚激情AV一区二区三区| 在线A亚洲老鸭窝天堂AV高清| 99久久免费看少妇高潮A片特黄| 亚洲A片成人无码久久精品青桔| 青青草免费线看v伊人| 欧亚又粗又大又黄的A片| 男女激情无遮挡免费视频| 99国内偷揿国产精品人妻| 日产精品一卡2卡三卡四| 欧美人牲交A欧美精区日韩| 精品国产福利一区二区在线| 精品欧美成人无码专区毛片视频| 日韩美女乱淫试看屁视频网站| 欧美又粗又猛又爽又黄A片| 一个色综合国产色综合| 大学生做爰全过程免费的视频 | 国产午夜精品一区二区三区嫩草| 亚洲AV无码A片一二三区| 中文字幕一区二区视频| 久久亚洲精品国产露脸| 俄罗斯6一12呦女精品| 欧美乱码1卡2卡三卡4卡| 国产日韩一区二区三免费高清| 精品日韩二区三区精品视频| 日韩亚洲国产中文字幕欧美| 久久国产Av无码一区二区老太| 亚洲卡2卡3卡4卡精品| 久久亚洲99精品无码中出| 2018最新福利天堂视频92| 2019久久久最新精品| 亚洲成色A片77777在线麻豆 | 欧美激情刺激爽免费视频观看 | cao死你小sao货湿透了| 亚洲精品久久久WWW| 男女做爰全A片免费的看| 无码丰满熟妇BBBBXXX| 在线看片av以及毛片| 99精产国品一二三产品香蕉| 色又黄又爽18禁免费视频| 色一情一乱一乱一区99AV白浆| 国产亚洲一卡2卡3卡4卡老狼| 亚洲精品久久片久久久久| 久久精品麻豆日日躁夜夜躁妓女| 两个人免费视频在线观看高清频道 | 胸大美女又黄的网站| e本大道1卡2卡三不卡| 亚洲AV久久久噜噜噜久久| 成人A片免费看男人社区| 大桥未久a 一区二区| 亚洲欧美色图小说| 无码激情做A爰片毛片A片蜜桃| 亚洲不卡一卡2卡三卡4卡5卡| 亚州久久久久区1区2少妇| 丰满少妇大力进入AV亚洲| 久久亚洲AV成人无码电影A片| 撸啊撸激情五月色| 无码人妻视频又大又粗欧美| 亚洲中文无码AV在线观看| 亚洲午夜精品A片久久软件| 久热视频这i里只精品| 欧美又粗又大AAAA片| 亚洲精品一区久久久久久| 国产乱码免费卡1卡二卡3卡四卡| 少妇人妻人伦A片| 亚洲中文字幕无码一久久区| 色情免费网址直接观看| 国产乱码免费卡1卡二卡3卡四卡 | 成人全黄A片免费看| 少妇高潮A片特黄久久精品网| 久久91精品国产91久久户| 少妇大叫太大太深受不了| 国产精品美女乱子伦高潮| 日本MATURE熟母| 精品熟女少妇AV久久免费软件| 熟女少妇人妻中文字幕| 国产乱码一卡二卡3卡4卡网站| 阿v天堂2018在无码免费| 韩国一区二区视频| 青青小草国产在线播放| 久久受www免费人成_看片中文| 夜来香AV在线观看| 久艾草在线精品视频在线观看| 欧美激情一区二区A片成人| 丁香六月久久婷婷开心| 风韵饥渴少妇在线观看| 亚洲情综合五月天| EEUSS鲁丝片直达入口音响| 最近最好最新2019中文字幕免费 | 国产人妻人伦精品98| 成人MV射精无打码视频| 免费观看少妇全黄A片| 日产国产欧美韩国在线| 最近更新中文字幕免费完整版| 亚洲 素人 字幕 在线 最新| 丰满少妇乱A片无码| 国产AA久久大片日本无码| 麻豆一二三四区乱码| 影视AV久久久噜噜噜噜噜三级| 日产A一A区二区WWW| 九色终合九色综合88| 成人无码A片在线观看| 日本无码免费A片无码视频| 无码人妻AV久久久一区二区三区 | 乡下妇乱子伦小说| 国产精品人妻出轨AV大片| 91无码人妻精品国产色情竹菊影视| 69精品国产久热在线观看| 色欲av亚洲情无码av蜜桃| 亚洲一区二区观看播放| 久久久久久久一线毛片| 日韩精品欧美视频| 日本毛片久久国产精品| 奇米影视7777久久精品人人爽 | 日产精品一卡2卡三卡四| 噼里啪啦在线高清观看免费| 女心理师电视剧在线观看完整版| 无码高潮又爽又黄A片软件| 久久久久久久国产免费看| GOGO人体做爰AAAA免费| 精产国品一二三产区M553| 欧美黑人添添高潮A片视频| 久久久精品色情天美| 亚洲精品成人无限看| 男女两性做爰全过程A片| 女人被狂躁到高潮呻吟小说| 无码免费人妻A片AAA毛| 久久久久久国产视频| 少妇夹得好紧太爽了A片| 亚洲精品国产A久久久久久| 成人无码T髙潮喷水A片小说| 欧美日韩精品一区二区三区高清视频| 亚洲成AV人片一区二区三区| 色情无码鲁鲁A的电影| 亲胸摸下面激烈免费网站| 欧亚成人A片一区二区| 国产亚洲精品久久久久久一区二区| 丰满少妇被猛烈进入毛片| 中国欧美日韩一区二区三区| 伊人狠狠色丁香婷婷综合男同| 日韩一级精品久久久久| 国产福利一区二区三区在线视频| 无码国产一区二区三区四区| 无码人妻视频又大又粗欧美| 狠狠色丁香婷婷久久综合| 日本私人VPS一夜爽毛| 国产AV亚洲精品久久久久软件| 亚洲精品久久久无码| 亚洲成人视频在线观看| 高清无码国内自拍视频| 久久精品国产免费中文| 四虎影库永久地址发布| 免费一区二区三区无码A片| 少妇精品偷拍高潮系列小说| 亚洲AV成人天堂影院| 无码中文字幕AV久久专区| 乱码一二三四视频不卡| 男人吃奶摸下边特黄A片| 久久视频这里只精品99re8久| 国产亚洲精品成人AA片小说| 人妻互换AV无码打压3p| 日本吻胸视频成人A片无码| 日本妇人成熟A片一区-老狼| 无码强伦姧A片在线观看| 亚洲色无码A片一区二区情欲| 亚洲精品无码A片一区二区三区| 国产精品美女乱子伦高| 国产人妻spa按摩在线91| 免费区大尺码体验区| 日韩A片无码一区二区五区电影| 无码精品人妻一区二区三A片 | 欧美日韩中文国产一区发布 | 中无码人妻丰满熟妇啪啪18禁| 黑人精品欧美一区二区蜜桃| 国精产品99永久中国有限| 搡BBBB搡BBB搡五十| 九九精品超级碰视频| 成人午夜精品无码区久久漫画日本| 日本成熟少妇高潮A片| 无码中文字幕无码一区日本| 免费看成人AA片无码视频羞羞网| 国产午夜精品一区二区三区四区 | 无码精品一区二区三区在线A片| 最近中文字幕免费国语6| 波多野结衣无码一区二区在线播放| 中文字幕va一区二区三区| 精品国产乱码久久久久久1区2区-亚洲| 国产精品人妻一码二码| 51精产国品一二三产区区别| 最放荡的熟女人图片| 成人天堂婷婷青青视频在线观看| 奇米影视7777久久精品人人爽| 日本添下边无码视频| 亚洲精品久久无码AV片软件| 亚洲50熟女性视频免费| 色情毛片AAAAAA片毛片| 亚洲乱码一卡2卡3卡四卡| 亚洲AV怡红院AV男人的天堂 | 国产一卡三卡四卡无卡精品| 亚洲色婷婷久久精品AV蜜桃小说| 777片理伦片在线观看| 少妇人妻邻居做爰无码| 国产成人AAAAA毛片一区永久| 阿v天堂2018在无码免费| 国产亚洲精品久久久久久一区二区 | 亚洲欧美日韩在线观看一区二区三区 | 免费一级做a爰片久久毛片潮喷 | 国产久热在线观看视频 | 国产亚洲AV综合一区二区A片| 欧美内射深插日本少妇| 久久久精品久久久久久久久久久| 真人性做爰A片免费| 成人网站免费大全日韩国产 | 亚洲成人视频一区二区| 亚洲熟少妇在线播放999| 美女大BXXXXN内射| 亚洲精品免费在线| 欧美日韩免费在线| WWW夜片内射视频日韩精品成人 | 懂色Av一区二区三区四区在线播放| 人妻互换AV无码打压3p| 欧美日韩久久久精品A片| 免费A片全黄少妇7777| 无码人妻一区二区三区A片| 色拍拍在线精品视频| 欧洲精品XXX与兽交| 国产精品高清视亚洲一区二区| 少妇性BBB搡BBB爽爽爽| 最近最新中文字幕大全手机| 久久精品免费人成人A片| 日本国产精品无码字幕在线观看| 高清无码国内自拍视频| 欧美又大又色又爽AAAA片| 日韩国产网曝欧美第一页| 色情按摩XXXX视频| 亚洲A片永久精品无码APP| 国产人A片在线乱码视频| 国产成人无码免费看视频软件| 欧美又粗又大又黄A片| 麻豆乱码一卡二卡三卡视频| 邻居少妇被爽到高潮A片| 阿v2019天堂官网| 69无码人妻互换A片| 日本A片中文字幕精华液| 亚洲一区二区三区四区五区六| 国产成人精品日本亚洲11| 亚洲精品久久国产精品37P| 亚洲AV久久无码精品九九软件| 成人A片一区二区三区在线观看| 久久久无码精品亚洲A片0000| 免费做爰猛烈吃奶摸视频在线观看 | 国产激情无码激情A片免费软件| 丰满少妇猛烈进入A片88| 亚洲国产中文在线视频| 天天看片视频免费观看| 男人天堂网夜色99视频| 亚洲精品久久久久久久爆乳电影| 国产麻豆剧果冻传媒视频免费| 国产精品热久久高潮AV袁孑怡 | 亚洲一区二区无遮挡A片| 亚洲精品蜜夜内射| 99麻花豆传媒剧国产| 极品JK小仙女自慰喷水牛牛影视| 国产一卡 二卡三卡四卡无卡乱码视频 | 国产小视频免费在线观看| 肥婆巨肥BBBwBBBwBBW| 高潮无遮挡成人A片| 久久国产欧美日韩精品免费| 日本私人一二三四区色欲| 欧美黑人一区二区三区免费A片 | 高清国产MV视频在线观看| 日本少妇BBW丰满做爰| 亚洲精品成人无码一区二区三区 | 久久中文字幕无码A片不卡| 亚洲AV怡红院AV男人的天堂| 扒开粉嫩尿口露出大胸美女| 成人免费午夜在线观看| 好硬啊一进一得太深了A片69 | 无码免费人妻A片AAA毛 | 少妇性BBB搡BBB爽爽爽欧美| 亚欧日韩毛片在线看免费网站 | 久久视频在线视频观看 99| 精品亚洲卡一卡2卡三卡乱码 | 中文字幕无码人妻少妇免费视频| 国产精品VIDEOSSEX久久发布 | 成人网站免费大全日韩国产| 国产欧美日韩另类精彩视频| 少妇高潮呻吟A片免费看小说 | 日韩免费A片奶头| 亚洲中文字幕无码专区日本苍井空| WWW国产亚洲精品久久| 欧美国产日韩综合无码 | 少妇无码太爽了不卡视频在线看| 亚洲精品国产乱码AV在线观看| 国语熟妇乱人乱A片久久| 亚洲综合无码一区二区| 超碰97天天蜜臂人人天天| 欧美黑人狂躁日本妞免费视频| 又硬又粗进去好爽A片免费多人玩| 免费人欧美成又黄又爽的视频| 成人做爰高潮A片免费视频| 国产人妻人伦AV又粗又一长| 91久久精品国产亚洲| 一线免费视频BD高清| 国产精品日韩欧美一区二区三区| 在线视频夫妻内射| 国产做A爱片久久毛片A片秋霞| 亚洲午夜视频在线观看| 国产美女裸体无遮挡免费视频网站| 性XXXXX搡XXXXX搡景甜| 日韩人妻色情欲网站德国熟妇AV| 日本无码人妻丰满熟妇A片| 交1300合集欧美成人性| 一女被两男吃奶添下A片 | 男女做爰猛烈吃奶摸大胸| 日韩一卡二卡三卡四卡免费观在线 | 欧美乱妇无码大片在线观看| 哪灬你的鸣巴好大好爽| 亚洲国产精品日本无码小说| 国产揉捏爆乳巨胸挤奶视频| 欧美黑人狂躁日本妞免费视频| 欧美人与性囗牲恔配的起源| “顶XX”“街X”“痴汉XXX| 69久久无码一区人妻A片| 五月久久丁香花婷婷欧洲| 久久国产免费观看精品1| 啦啦啦WWW中文视频| 精品成人无码A片免费软件| 国产亚洲精品久久7788| 狠狠躁夜夜躁人人爽A片| 欧美丰满熟妇BBB久久久| 国产精品人妻出轨| 2019年92午夜视频福利| 韩国免费A片爱的人蜜爱| 无人区码一码二码三| 国产成人综合亚洲A片激情文学| 99久久精品国产毛片鲁一鲁| 亚洲一区二区三区无码中文A片| 久久99爱re热6在线播放| 亲子乱AⅤ一区二区三区的| 亚洲精品久久久一区| 自怕偷自怕亚洲精品| 最近2018年中文字幕大全视频| 成人午夜精品网站在线观看| 日韩一卡2卡3卡无卡新区乱码| 久久天天婷婷五月俺也去| 国产乱妇无乱码大黄AA片| 亚洲婷婷国产精品电影人久久| 搡BBBB推BBBB推BBBB| 亚洲 欧美 自拍 美腿 卡通| 少妇我被躁爽到高潮A片白洁| 国产福利在线免费| 成人爱爱激情高潮A片| 一本久道久久综合婷婷五月| 強奷漂亮少妇高潮A片P夜夜嗨| 欧美一区二区在线观看| 在线观看黄A片免费AV软件| 国精品无码一区二区三区在线A片 国产乱子经典视频在线观看 | 爱我几何高清完整版| 精品麻豆剧传媒AV国产| 激情五月色综合国产精品| 欧洲一卡2卡3卡4卡免费观看 | 亚洲精品嫩草AV在线观看| 日本无码熟妇人妻在线视| 又大又粗成人A片免费看| 噜噜噜AV在线观看| 成人无遮挡18禁免费视频| 亚洲国产欧美日本视频| 日本一卡二卡三卡四卡手机免费观在线 | 国产精品高潮呻吟AV久久动漫| 无码国产一区二区三区四区| 久久久久久久国产精品视频| 久久免费视频精品在线| 免费播放一区二区三区| 亚洲一卡2卡三卡4卡无卡下载| 欧美精品3atv一区二区三区 | 国产大尺度吃奶无遮无挡| 四个熟妇搡BBBB搡BBBB| 中文字幕日产A片在线看| 天天看片视频免费观看| 亚洲精品1卡2卡三卡4卡乱码| 日本老熟妇人妻妇毛多多| 亚洲男人天堂2018av| 亚洲精品无码AAAAAA片| 亚洲国产成人A片乱码| 老女人熟女人妻国产| 国产亚洲精品久久AV| 男女做爰猛烈吃奶摸大胸 | 乱码一二三四视频不卡| 97亚洲熟妇自偷自拍另类图片| 亚洲A片国产AV一区无码| 天堂网在线新版WWW| 两个人免费视频在线观看高清频道 | 国产激情视频在线观看首页| 正在播放夫の前で痴汉に绝顶| 欧美黑人性受XXXX精品| 办公室做爰A片视频| 91久久国语露脸精品国产高跟| 少妇看A片偷人精品视频| 亚洲精品久久久AV无码专区| 亚洲精品无码高潮喷水A片在线 | 国产真人做爰视频免费| 黑人狂躁日本妞无码视WWW| 韩国乱码卡一卡二卡新区网站| 国产欧美日韩A片免费软件| 66亚洲一卡2卡3卡四卡新区| 亚洲精品一区久久久久久| 天堂俺去俺来也www色官网| 99久久精品免费看国产一区二区| bl版完全性感48招| 亚洲精品久久无码AV片WWW| 丰满少妇乱A片无码| 国产传媒18精品A片在线观看| 四川少BBB搡BBB爽爽爽| 亚洲精品国产综合AV在线观看| 日本又黄又无无遮无码视频| 亚洲色无码A片一区二区情欲 | 亚洲精品久久无码AV片亚洲| 国产在线看片免费视频| 亚洲50熟女性视频免费| 中文在线っと好きだっ| 久久草香蕉频线观| 爱如潮水免费5观看视频韩国| 日韩色情无码一本二本三本| A片又大又粗又爽免费视频| 中文文字幕文字幕亚洲色| 裸体女人高潮A片| 中文字幕色综合久久| 日本一卡二卡三卡四卡无卡在线观看免费软件 | 亚洲精品国产不卡在线观看| 欲妇荡岳丰满少妇A片| 男人的天堂亚洲一线AV在线观看 | 69无人区码一码二码三码| 免费看国产成年无码A片| 55夜色66成年视频观看免费| 国产少妇人妻 在线播放| 免费又粗又硬进去好爽A片视频| 精品AV一区二区三区久久| 丰满人妻熟妇乱又伦精品劲| 两个人免费视频在线观看高清频道 | 欧美乱妇日本无乱码特黄大片 | 亚洲人成色777777老人头| 亚洲精品无码成人A片在线软件| 国产色婷婷亚洲99精品| A天堂最新版在线中文| 色偷偷在线视频直播| 江苏少妇性BBB搡BBB爽爽爽| 久久久人妻无码A片一区二区三区 白丝高中生被C到爽哭视频 | 久久久无码精品亚洲A片0000| 国产区免费在线观看| 男人把我添到了高潮A片| 国产午夜亚洲精品国产| 成人无码区免费A片视频日本| 亚洲成人一区二区| 国产97精品无码A片在线看密| 开心五月丁香花综合网| 亚洲精品成AV人片天堂无码 | 精品国产91乱码一区二区三区| 花蝴蝶电视剧高清免费观看| AAA级无码肉欲免费看| 日日噜噜大屁股熟妇AV张柏芝| 免费做A爰片久久毛片A片下载| 成人做爰高潮A片免费视频| 亚洲一区二区无遮挡A片| 在线视频一区二区三区在线播放| 日产乱码一二三区别免费仙踪林 | 西西人体bb高清大胆| 播五月开心婷婷欧美综合| 拔萝卜视频免费看高清| 国产精品久久人妻无码A片| 玩异少妇一区二区A片| 波多野结衣高清videossex| 91在线视频免费看| 久久久久久久久久久96av| 妇少水多17P密泬18P| 亚洲AAAA片色欲aV| 久久免费看少妇高潮A片特黄多| 99国产在线视频有精品视频| 成人免费永久在线观看视频| 我揉着老师白嫩的大乳| 亚洲AV久久久久久久无码| 99国产精品久久久久久久日本竹 | 麻花豆传媒剧国产免费MV在线 | 91人妻人人澡人人爽人人精品投稿 | 欧美精品久久久久久无码人妻| 亚洲精品综合一区二区三 | 欧美黑人添添高潮A片视频| 久久精品中文騷妇女内射| 日日摸天天摸人人看| 国产精品成人无码A片免费网址| 噼里啪啦免费观看高清动漫| 成人国产在线不卡视频| 精品国产天堂综合一区在线| 精品AV亚洲一区二区| 亚洲一区二区在线老片| 日本吻胸视频成人A片无码| 无线日本视频精品| 在线中文天堂最新版官网| 日日鲁鲁鲁夜夜爽爽狠狠| 亚洲精品一区久久久久一品AV| 亚洲精品乱码8久久久久久日本| 1级午夜影院费免区| 日本网站网站大全A片| 日日鲁鲁鲁夜夜爽爽狠狠| 视频一区国产精戏刘婷30 | 搡女人真爽免费视频网站| 国产成人手机高清在线观看网站| 搡老熟女老女人一区二区| 久久精品AV一区二区无码| 欧美一区二区高清| 亚洲精品无码成人A片九色播放| 成人亚洲区无码偷拍12P| 亚洲精品久久久久久一区| 成人免费午夜在线观看| 亚洲二区在线视频| 少妇性BBB搡BBB爽爽爽| 精品国产高清毛片A片看| 人妻激情综合久久久久| 琪琪电影网www888dvdc| 国产在线看片免费视频| 又硬又粗进去好爽A片免费多人玩 456亚洲人成影院在线观 | 噼里啪啦免费观看高清动漫| 国产特黄级AAAAA片免| 免费观看少妇全黄A片| 无遮挡BBBBB级A片| 四川少妇BBB凸凸凸BBB按摩| 人人妻人人澡人人爽人人老司机| 人人爽人妻精品A片二区| 无遮无挡试看120秒高潮| 天堂中文www资源在线| 精品久久久久久久久久久下载| 日本私人VPS一夜爽毛| 久久久九色综合亚洲成色777| 国产免费又色又爽又黄软件| 高清无码午夜福利在线观看| 免费看少妇高潮A片黄| caoporn国产精品免费视频| 日本久久精品视频| 久草原精品资源视频| 亚洲第一男人天堂| 无码成人AAAAA毛片| 国产精品一区二区在线播放| 无码中文字幕无码一区日本| 大杳蕉中文在线看大杳| 欧美两女被1男所奸1级性爱大黄片| 亚洲情A成黄在线观看动漫软件| 亚洲精品综合五月久久小说| 1000部毛片A片免费观看 | 日本妇人一成熟A片高潮| 卡一卡二卡三无人区乱码入| 国内精品久久久久久网站| 日韩精品午夜视频一区二区三区| 特级做A爰片久久毛片A片喷水 | 真人做爰片免费视频毛片中文| 免费无码一线A片AAA片| 99成人做爰A片免费看网站| 亚洲乱码高清午夜理论电影| 日韩乱码卡1卡2卡三卡四卡| 欧美又粗又长又大AAAA片| 东北农村小伙GAY与老大爷| 日本理伦少妇4做爰| 亚洲午夜精品A片久久WWW解说| 丰满多毛少妇做爰视频爽爽和R | 国产又黄又猛又粗又爽的A片小说| 日本A片大尺度高潮无码| 无套内射视频囯产| 尤物在线精品视频| 在线中文天堂最新版官网| 成熟妇人A片免费看网站| 亚洲av免费在线观看| 国产又爽又粗又猛的视频A片| 中文字幕熟女人妻伦伦在线 | 蜜臀AV999无码精品国产| 91蜜桃传媒吹潮粉嫩少妇| 偷偷鲁手机在线播放AV| 免费无码片AV在线观看| 国产69精品久久久久人妻刘玥| 丰满人妻无码AV一区二区免费| 少妇的肉体AA片免费| 中文字幕一区二区三区人妻少妇在线| 噼里啪啦国语版在线观看| 中文天堂最新版在线| 久久国产伦子伦精品| 亚州日韩精品AV片无码中文| 亚洲中文字幕久久精品无码喷水| 久久亚洲精品AV无码四区| 国产亚洲精品久久久久久禁果TV| ●苍井そらVIP破坏流出无码| 亚洲精品成人无码一区二区三区| 欧美射精网站下载含羞草| 我和嫲嫲狂躁了一晚上还住| 午夜精品白在线观看| 精品人妻熟女一区二区三区免费看| 老司机午夜免费精品视频| 伊人大杳蕉在线影院在线播放| 亚洲蜜桃精久久久久久久久久久久 | 亚洲精品国产综合AV在线观看| 亚洲人成人网毛片在线播放| 国产亚洲精品久久久性色情软件| 国产精品久久久久久久久久久久 | 欧洲精品XXX与兽交| 午夜尤物禁止18点击进入| 婷婷伊人綜合亞洲綜合網| 男女做爰猛烈啪啪吃奶图片| 西西欧美大胆无码视频比基尼| 亚洲 暴爽 AV人人爽日日碰| 少妇寂寞被按摩师| 久久无码精品一区二区三区第1集| 国产又黄又猛又粗又爽的A片动漫| 色婷婷AV久久久久久久| 亚洲国产欧美中文手机在线| 強奷漂亮少妇高潮A片P夜夜嗨| 中文字幕乱码中文乱码777| 人妻精品久久无码区新狼窝| 一本一道AV一区二区三区| 精品视频一区二区三三区四区| 国产成人无码免费看视频软件| 成人亚洲区无码偷拍| 九九99热久久999精品| 亚洲AV色情偷拍精品| 高潮失禁喷水流白浆无码| 亚洲精品无码国产爽快A片百度| 国产精品A一区二区三区腾讯导航 国产午夜亚洲精品国产 | 精品国产乱码久久久久久夜深人妻| 亚洲国产精品一区二区第一页| 久久久人精午夜精国| 国产午夜免费视频片夜色| 成人片黄网站A片免费| 国产精品亚洲精品久久久久| 欧美日本国产VA高清CABAL| 少妇看A片偷人精品视频| 美女把尿囗扒开让男人添| 国产大尺度吃奶无遮无挡| AV色情抓胸吃奶免费观看| 成人做爰WWW免费看视频日本| 久久99热在线观看7| 永久免费看A片无码播放器不卡| 99国精产品一区二区三区A片| 真人裸交120秒试看| 国产V日产∨综合V精品视频麻豆| 国产精品成人无码A片免费软件| 五月婷婷开心 中文字幕| 国产精品久久..4399| 终极蜘蛛侠动画片全集| 女人高潮抽搐AAA| 成人亚洲色欲色一欲WWW| 亚洲乱熟乱熟女一区二区| 亚洲精品久久久无码| 宅男宅女做a天堂| 狼狼躁日日躁夜夜躁A片| 日韩一卡2卡3卡4卡乱码网站导航 亚洲国产欧美日本视频 | 插的痛的视频一卡二卡三卡| 日韩欧美视频一区二区| 久久久国产精品免费A片分天美| 欧美精品无码久久久潘金莲| 日本老妇一级特黄aa大片| 国产色情一区二区不卡毛片| 国产激情无码激情A片免费软件| 精品人妻无码一区二区三区在线 | 亚洲精品九色在线网站| 国产美女被爽到高潮免费A片| 男人的天堂av社区在线| 亚洲中文字幕婷婷在线| 又大又爽又黄无码A片片一级视频| 国产成人精品久久一区二区三区| 做A爰片久久毛片A片的价格| 中出人妻中文字幕无码| 日产区一线二线三AV| 免费无码国产色情在线APP| 免费A片国产毛A片无码久久| 国产卡二卡三卡四卡免费网址| 少妇荡乳情欲办公室456视频| 国产69精品久久久久久人妻精品| 人妻仑乱A片免费| 性按摩玩人妻HD中文字幕| 四LLL少妇BBBB槡BBBB| 无码精品一区二区在线A片软件| 国产麻豆剧果冻传媒视频免费| 亚洲国产中文在线视频| 国产高清乱理伦片中文小说| 无码人妻深夜拍拍AAA片| 色欲av亚洲情无码av蜜桃| 美女大BXXXXN内射| 久热在线这里只有精品7| 免费阿v网站在线观看g| 日产无人区一线二线三线小说| 亚洲 日本 欧洲 欧美 视频| 在线观看视频免费精品视频| 国产黃色A片三級三級三級四川| 欧美性猛交AAAA片黑人| 国产福利一区二区三区在线视频 | 国产在线视频精品视频| 日本妇人成熟A片一区-老狼| 国产 高清 无码 在线播放| 国产午夜高潮熟女精品AV| 国产情侣疯狂作爱系| 成人无码区免费A片WWW| 亚洲A片国产AV一区无码| 免费无码一线A片AAA片| 久久久精品理论A级A片| 日日摸天天摸人人看| 在线青青视频免费观看| 无码AV亚洲一区二区毛片| 小sao货揉揉你的奶真大电影| caoprom最新超碰地址| 八戒八戒在线观看免费观看高清8| 国产色情18一20岁片A片下载| 影音先锋a色情av资源| 亚洲无码精品在线观看| 在线观看日韩一区| 久久久高清国产999尤物| 影音先锋av色噜噜影院| 中文字幕人妻熟女在线| 成年黄网站免费大全毛片| 国产精品呻吟AV久久高潮| 永久黄网站色视频免费| 国产亚洲精品久久久性色情软件| 中文天堂网WWW新版资源在线| 人妻丰满熟妇V无码区A片免费看| 97人妻成人免费视频| 精品日产1卡2卡三卡入口最新版| 亚洲精品色情婷婷在线播放| 粉嫩入口处粗黑进进出出BL | 国产特黄级AAAAA片免| 艳妇荡岳丰满交换做爰电影| 久久国产天堂福利天堂| 中国老太丰满毛耸耸| 国产AA久久大片日本无码| 亚洲精品久久无码AV片WWW| 老女人与小伙子露脸对白 | 女女女女BBBBBB毛片视频| 少妇被躁爽到高潮无码A片小说| 啦啦啦中文日本免费高清百度| 4399少妇做受免费A片| 欧美顶级少妇做爰HD| 丰满人妻中伦妇伦精品APP| 一级做a爰片久久免费| 亚洲欧美日本久久综合网站| 亚洲卡2卡3卡四卡乱码 | 亚洲男人97色综合久久久| 无忧传媒剧国产剧情MV在线| 亚洲男人片片在线观看| 最近最好最新2019中文字幕免费 | 女人性做爰100部免费| 国产乱妇无码大黄AA片| 日本A片大尺度高潮无码电影 | 亚洲色欲色欲在线大片| 中文字幕人妻熟女在线| 九九精品国产亚洲A片无码| 少妇BBB搡BBBB搡BBBB| 久久久无码精品亚洲A片0000| 奇米影视第四色av首页| 亚洲精品日韩一区二区电影 | 亚洲丰满熟女一区二区蜜桃| 人与人和人与物XXX| jlzzzjizzzjlzzz亚洲| 麻豆精品一区二区三区Av沈娜娜| 亚洲AV国产成人精品区三上悠亚 | 四川少妇BBBB槡BBBB槡| 亚洲一区AV在线观看无码漫画| 老人性做爰A片老妇人| 亚洲精品1卡2卡三卡4卡乱码| 西西人体大胆瓣开下部毛茸茸| 欧美做爰猛烈动高潮视频| 噼里啪啦国语版在线观看| 亚洲综合网国产精品一区| 真人做爰高潮全过程| 国产AV99激情久久无码天堂| 国精产品一码一码三mba| 亚洲精品无码高潮喷水A片在线| 国产精品久久人妻无码网站一区L| 欧美内射深插日本少妇| 日韩精品无码A片一二三区| WWW国产亚洲精品久久小说| 人妻精品久久无码专区色视蜜臀| 成人亚洲精品久久久久| 日韩一卡2卡3卡4卡乱码网站导航| 国产色情18一20岁片A片| 欧日韩无套内射变态| 永久免费看A片无码播放器不卡| 97亚洲狠狠色综合久久久久| 日出水了啊快点使劲动态图| 国产精品 同事 在线 视频 | 我学生的妈妈双字ID5| 特黄AAAAAAA片免费视频| 风韵饥渴少妇在线观看| 成熟少妇AV片在线观看| 国产小视频免费在线观看| 午夜妇女AAAA区片| 男女做爰猛烈吃奶摸大胸| 免费看毛片的网址| 男人撕开奶罩揉吮奶头GIF| 国产亚洲精品成人AA片小说| 又大又粗又爽免费视频A片| 欧美又大又粗无码视频| 久久草这在线观看免费| 三个老外与一女做爰视频| 久久久无码精品亚洲A片0000| 国产色精品久久人妻无码看| 免费做A爰片久久毛片A片| 最好最新高清中文字幕| 欧美群伦性艳史黄94| 先锋影音avt天堂影院| 日本又色又爽又黄的A片视频免费| 97伦伦午夜电影理伦片| 悟空影视免费观看视频| 人妻边做边看A片| 奶涨边摸边做爰69式视频| 亚洲精品久久久无码| 成人午夜视频一区二区国语| 国产亚洲一卡2卡3卡4卡老狼| 国产成人无码免费看视频软件| 欧美又粗又深又猛又爽A片| 人妻丰满熟妇V无码区A片免费看| 久久久九色综合亚洲成色777|